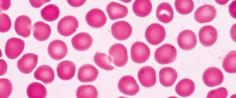

Studio



SCIENZE e TECNOLOGIA + Eserciziario
Pop Podcast
Educazione Civica
STEM lab
Pagine Atlante

![]()



Pop Podcast
Educazione Civica
STEM lab
Pagine Atlante

Lo scheletro
Il cuore
41 Il cervello I polmoni
42 Il corpo umano
43 Le cellule
44 I tessuti
45 Organi, sistemi e apparati
46 Il sistema scheletrico
47 Le ossa • Le articolazioni
48 Il sistema muscolare
49 Muscoli e movimento
50 ATLANTE
Il sistema scheletrico • I muscoli scheletrici
52 L’apparato respiratorio
53 La respirazione
Inspirazione: l’aria entra nei polmoni • Espirazione: l’aria esce dai polmoni
54 L’apparato digerente
55 I denti
56 La digestione
57 L’apparato urinario
Come funzionano i reni
58 EDUCAZIONE CIVICA
Obiettivo 3: salute e benessere
60 DALLA SINTESI...
61 ALLA MAPPA
62 POP PODCAST LO SPORT
63 STEM LAB L’osso nell’aceto
64 VERIFICA LE TUE CONOSCENZE Il corpo umano • 1
66 L’apparato riproduttore
L’apparato femminile • L’apparato maschile
67 Dalla fecondazione alla nascita
68 L’apparato circolatorio
I vasi sanguigni
69 Il sangue
70 Il cuore
La struttura • La funzione
71 La circolazione del sangue
72 ATLANTE
L’apparato cardiocircolatorio • Il cuore
73 Il sistema nervoso

74 Il sistema nervoso centrale
L’encefalo • Il midollo spinale
75 Il sistema nervoso periferico
Nervi sensitivi e organi di senso • Nervi autonomi: simpatici e parasimpatici
76 L’occhio e la vista
L’occhio esterno • Il bulbo oculare
77 Lorecchio e l’udito
L’equilibrio
78 Il naso e la lingua
I recettori dell’olfatto • I recettori del gusto
79 La pelle e il tatto
80 DALLA SINTESI...
81 ALLA MAPPA
82 POP PODCAST IL CERVELLO
83 GIOCA CON POP
84 VERIFICA LE TUE CONOSCENZE Il corpo umano • 2
86 io e... le SCIENZE
87 ESERCIZIARIO

Ciao, sono sempre Pop e sarò con voi anche nell’ultimo anno di scuola primaria. Vi porterò a conoscere il vostro corpo, ma anche l’energia, il motore di ogni cosa, e il nostro pianeta visto dallo spazio.

Quante cose usiamo che hanno bisogno di energia!
Ti sei mai chiesto da dove arriva la forza che fa funzionare tutte le nostre cose?





La nostra meravigliosa casa, la Terra! Ti sei mai chiesto perché appare così blu vista dallo spazio? E cosa sono le chiazze bianche che vedi? Quante cose incredibili ci aspettano da scoprire su questo pianeta unico!
METODO P O P
P RIMA O SSERVO P OI... RIFLETTO

Guarda come è forte e scattante il corpo di un atleta. Ma quanti muscoli abbiamo in tutto? E cosa dobbiamo fare per mantenere in salute e far funzionare bene tutto il nostro corpo?

Osservate attentamente le immagini della pagina. Discutete in piccoli gruppi le domande che le accompagnano: cosa vi colpisce di più in ogni foto? Provate a rispondere a questa domanda: cosa accomuna un corpo forte e scattante a un pianeta ricco di vita e alla forza che accende le nostre lampadine? Scrivete una frase per ogni immagine che riassume la vostra idea principale.


Astronomia: è la scienza che studia i corpi celesti; la parola viene dal greco àstron, che significa stella.

La sonda spaziale Schiapparelli ha raggiunto Marte, portando sul pianeta strumenti che inviano segnali alla Terra.
Da sempre il cielo notturno suscita meraviglia e curiosità in chi lo osserva.
Oggi l’astronomia ci dice che l’Universo è molto più vasto di quello che possono aver immaginato i nostri antenati. Esso comprende miliardi di galassie, che sono giganteschi ammassi di stelle, gas e polveri. Ogni galassia, a sua volta, contiene da qualche milione a migliaia di miliardi di stelle, cioè di grandi corpi gassosi che producono luce e calore. Spesso, poi, una stella è attorniata da corpi più piccoli, pianeti con i loro satelliti, che insieme alla stella stessa formano un sistema stellare.
La Terra su cui viviamo è un pianeta; fa parte del Sistema Solare, cioè del si stema della stella-Sole. La Luna, invece, è il satellite della Terra.

CURIOSITÀ POP
Il Sistema Solare si trova nella galassia Via Lattea. Si chiama così perché possiamo vederla come una fascia di luce soffusa nel cielo notturno (se è terso e non ci sono luci intorno): è costituita da miliardi di stelle che i nostri occhi non riescono a distinguere.

Le stelle visibili in tutta la volta celeste, in una notte limpida e buia, sono circa 6000.
Fin dall’antichità gli uomini le hanno raggruppate in costellazioni, per poterle riconoscere e, così, utilizzarle per orientarsi. Quando non c’erano mappe o telefoni, guardavano le stelle per capire dove andare, proprio come un “GPS” fatto di stelle! Hanno tracciato fra esse linee immaginarie, come quando si uniscono i puntini per formare un’immagine, e hanno attribuito alle forme che ne derivavano nomi legati a episodi mitologici.
La costellazione più nota è quella dell’Orsa Maggiore, detta anche Grande Carro. Una delle più belle è invece Orione che, secondo la mitologia, era un cacciatore cieco amato dalla Luna. Vicino a Orione puoi riconoscere Sirio, la stella più splendente di tutto il cielo.
La Stella Polare, che indica il Nord, si trova invece nella costellazione dell’Orsa Minore, o Piccolo Carro.
SVILUPPO LE COMPETENZE
RICERCO E OSSERVO

Per osservare le costellazioni, come un vero astronomo, puoi utilizzare Stellarium, un software gratuito che permette di utilizzare il PC come se fosse un planetario.
● Collegati al sito https://stellarium-web.org/ e comincia a navigare tra stelle, pianeti e asteroidi.
● Dal sito puoi anche scaricare l’app da usare su dispositivi mobili.
MARGHERITA HACK, LA “SIGNORA DELLE STELLE”
Margherita Hack era una scienziata che si occupava di astrofisica.
È nata a Firenze nel 1922 e ha passato la sua vita a studiare e scoprire cose nuove su ciò che vediamo nel cielo. È stata una delle poche donne scienziate del suo tempo e ha fatto capire a tutti che anche le bambine possono diventare grandi scienziate! Ci ha insegnato che è importante essere curiosi, studiare e non avere paura di fare domande, perché è così che si scoprono cose nuove. Diceva infatti che la scienza è come un’avventura: più si scopre, più si vuole sapere!

Il Sole e altri corpi celesti formano insieme il Sistema Solare, al quale appartiene il nostro pianeta, la Terra.

Il Sole, la stella che ci dà luce e calore, ha un diametro di circa 1 392 700 chilometri, pari a 109 volte il diametro terrestre (12 756 chilometri). Per avere un’idea della sua grandezza, osserva l’immagine di questa pagina, che ti mostra il Sole e i pianeti del sistema solare in proporzione di grandezza. Come tutte le stelle, il Sole è fatto di gas che bruciano, sviluppando calore e luce
All’interno del Sole si raggiungono temperature di milioni di gradi, mentre in superficie la temperatura è “solo” di 6000 gradi! Sulla superficie solare gli scienziati hanno individuato alcune zone scure chiamate macchie solari. L’osservazione del movimento di queste macchie ci fa capire che anche il Sole ruota su se stesso.
STUDIO CON METODO
LEGGO E COMPRENDO
Sottolinea nel testo le risposte alle seguenti domande.
● Qual è la stella del nostro sistema solare?
● Quanti e quali sono i pianeti?
● Come sono detti i satelliti?

● Dove si trova la maggior parte degli asteroidi?
● Quando diventano visibili le comete?
I pianeti
Sono otto corpi celesti che non emettono luce propria, ma riflettono quella del Sole. Essi orbitano attorno al Sole. Quasi tutti possiedono satelliti, detti anche lune, cioè corpi di dimensioni più piccole che orbitano attorno a essi.
Mercurio, Venere, Terra e Marte sono i pianeti più vicini al Sole. Sono detti pianeti interni o rocciosi, compresi tra il Sole stesso e la fascia di asteroidi. Quest’ultima è una regione del Sistema Solare piena di rocce e piccoli corpi chiamati appunto asteroidi. Giove, Saturno, Urano e Nettuno si trovano oltre la fascia degli asteroidi. Sono molto più grandi dei pianeti rocciosi e sono detti pianeti esterni o giganti gassosi Tutti e quattro hanno sistemi di anelli, alcuni dei quali non visibili con gli strumenti tradizionali.
Oltre a questi, vi sono tre pianeti nani, Cerere, Eris e Plutone (considerato fino a pochi anni fa il nono pianeta del sistema solare), numerosi asteroidi, e un certo numero di comete, corpi celesti costituiti principalmente da polveri ghiacciate, che diventano visibili solo quando si avvicinano al Sole e le polveri evaporano formando la chioma, cioè una nube luminosa.


Quando l’Italia si trova nella zona illuminata dal Sole, la parte opposta della Terra si trova nella zona d’ombra.
La Terra è il terzo pianeta interno del Sistema Solare. È il più grande dei quattro pianeti rocciosi. Ha la forma di una sfera leggermente schiacciata ai Poli.
La Terra si distingue dagli altri pianeti per:
● l’abbondanza di acqua allo stato liquido sulla sua superficie;
● la presenza di un’atmosfera.
Queste caratteristiche hanno reso possibile la comparsa della vita.
Il moto di rotazione terrestre
La Terra, come gli altri pianeti, compie un movimento di rotazione intorno al proprio asse, la linea immaginaria che congiunge i due Poli passando per il centro del pianeta.
La Terra ruota da Ovest verso Est. Per compiere un giro completo impiega 24 ore, cioè un giorno. Durante questo tempo espone una parte della superficie ai raggi solari, mentre la parte opposta rimane al buio. La linea immaginaria che separa le due parti si dice circolo di illuminazione.
Il movimento di rotazione determina, così, l’alternarsi di un periodo di luce, il dì, con uno di buio, la notte. Durante le 24 ore, a causa della rotazione, la superficie illuminata cambia continuamente. Al tramonto e all’alba ci troviamo vicini al circolo di illuminazione.

CURIOSITÀ POP
IL MOTO APPARENTE DEL SOLE
Dalla Terra il Sole ci appare in movimento, mentre sappiamo che è la Terra a ruotare.
Per capire come ciò avviene, immagina di essere su una giostra che gira: l’impressione è che sia il paesaggio a girare in senso opposto a quello in cui gira la giostra su cui ti trovi.
Il moto di rivoluzione terrestre
Come gli altri pianeti, oltre a ruotare su se stessa, la Terra orbita intorno al Sole. Questo movimento è chiamato rivoluzione e viene completato in 365 giorni e 6 ore, cioè in un anno solare. Poiché nei vari punti dell’orbita i raggi solari arrivano sulla Terra in modo diverso, si verificano periodi dell’anno più freddi o più caldi, cioè si alternano le stagioni. Esse sono invertite nei diversi emisferi: quando nell’emisfero settentrionale è inverno, in quello meridionale è estate e viceversa. Per capire come ciò avviene, osserva l’immagine: l’inclinazione dell’asse terrestre fa in modo che i raggi solari colpiscano la Terra più o meno obliqui, riscaldando una superficie più o meno vasta.
Se la luce arriva in modo obliquo sulla superficie terrestre, il riscaldamento è più debole e le ore di luce non sono molte: siamo in inverno.
Se la luce arriva quasi perpendicolare alla superficie terrestre, apporta una maggiore quantità di calore e le ore di luce aumentano: siamo in estate.
Raggi solari
Emisfero: ciascuna delle due metà della Terra, separate dall’Equatore.

Asse terrestre Inverno
Emisfero settentrionale
STUDIO CON METODO
COLLEGO E IMPARO
Collega ogni movimento terrestre alle sue caratteristiche.
● La Terra orbita intorno al Sole.
● La Terra ruota intorno al proprio asse.
● Il movimento ha la durata di 365 giorni.
● Il movimento dura 24 ore.
● È la causa dell’alternanza del dì e della notte.
● È la causa dell’alternarsi delle stagioni.
Emisfero meridionale

La Luna è il satellite della Terra. Non brilla di luce propria, ma riflette la luce del Sole. La sua superficie è costituita da rocce frammentate.
La Luna compie diversi movimenti:
● rotazione intorno a se stessa;
● rivoluzione intorno alla Terra;
● traslazione intorno al Sole insieme alla Terra.
La rotazione e la rivoluzione lunare hanno entrambe la durata di circa 27 giorni. Durante questo periodo, la forma della Luna ci appare diversa: sono le fasi lunari, che dipendono dalla posizione che la Luna assume rispetto alla Terra e al Sole.
Quando il Sole illumina completamente la faccia della Luna rivolta verso di noi, si ha la Luna piena
Quando la Luna si trova tra la Terra e il Sole, la faccia della Luna rivolta verso di noi non è illuminata, quindi non è visibile: si ha la Luna nuova.
Il primo e l’ultimo quarto di Luna ci appaiono nelle fasi intermedie tra la Luna nuova e la Luna piena.
STUDIO CON METODO
LEGGO E COMPRENDO
Completa ogni didascalia che si riferisce alle fasi lunari.


Luna piena Luna nuova Terra Primo quarto Ultimo quarto
Raggi solari
Raggi solari
Nella fase della Luna piena
il nostro satellite mostra a noi la faccia
Nella fase della Luna nuova il nostro satellite si trova tra
e mostra a noi la superficie


Il primo e l’ultimo quarto di Luna ci appaiono
La forza di gravità è una forza di attrazione che agisce tra due oggetti dotati di massa. Isaac Newton (1642-1727) fu il primo a formulare la legge di gravitazione universale: due corpi si attraggono tra di loro sia in rapporto alla massa che alla loro distanza. La forza di gravità aumenta con l’aumentare della massa e diminuisce con l’aumentare della distanza.
Il nostro pianeta ha una massa enorme. Per questo, la sua gravità è fortissima e attira verso il suo centro tutto ciò che si trova nelle vicinanze. È la gravità che ci tiene saldamente con i piedi per terra e determina il nostro peso. Più ci si allontana dal centro della Terra, più il nostro peso diminuisce.
La Luna esercita una forza di gravità sulla Terra. Questa forza attira leggermente l’acqua dei mari e degli oceani, provocando il movimento delle maree.
Quando l’acqua viene attirata verso la Luna, si crea l’alta marea.
Quando invece l’acqua si abbassa, si verifica la bassa marea.
Anche il Sole contribuisce alle maree, ma l’effetto della Luna è più forte perché è più vicina alla Terra.
SVILUPPO LE COMPETENZE
RIFLETTO E IMPARO
Massa: quantità di materia di cui è fatto un corpo.
Peso: forza con la quale un corpo è attratto per gravità da un altro corpo o dal centro della Terra.

Lontano dalla Terra la gravità è molto debole.

Gli effetti delle maree sul paesaggio
Indica con una ✘ se l’azione è resa possibile (SÌ) o è ostacolata (NO) dalla forza di gravità.
● Far cadere un sasso in uno stagno.
● Un palloncino pieno di elio che sale verso il cielo.
● La pioggia che cade dalle nuvole.
● L’acqua di un fiume che scorre verso valle.
SÌ NO
SÌ NO
SÌ NO
SÌ NO
L’Universo è l’insieme di miliardi di galassie
Ogni galassia contiene miliardi di stelle, cioè grandi corpi gassosi che producono luce e calore.
Una stella spesso è attorniata da pianeti con i loro satelliti, formando così un sistema stellare in cui si trovano anche asteroidi e comete.
Il Sistema Solare è formato da una stella, il Sole, e da altri corpi celesti minori: otto pianeti con i loro satelliti, un gran numero di asteroidi e alcune comete. I pianeti sono Mercurio, Venere, Terra, Marte, Giove, Saturno, Urano e Nettuno. Il Sistema Solare si trova nella Via Lattea.
La Terra è il pianeta su cui viviamo. La vita è possibile sulla Terra grazie all’abbondanza di acqua e alla presenza dell’atmosfera.
La Terra compie due movimenti:
• la rotazione intorno al proprio asse, che dura un giorno (24 ore) e determina l’alternarsi del dì e della notte;
• la rivoluzione intorno al Sole, che dura un anno (365 giorni e 6 ore) e determina l’alternarsi delle stagioni.
LA LUNA
La Luna è il satellite della Terra.



La Luna compie un movimento di rotazione su se stessa e di rivoluzione intorno alla Terra e questo periodo dura circa 27 giorni.
In questo periodo la Luna cambia aspetto in base alle fasi lunari.

Completa la mappa con l’aiuto delle parole chiave evidenziate nella pagina a fianco. Poi utilizzala per esporre a voce l’argomento.
DOV’È?
Nell’Universo, formato dall’insieme di galassie, composte da:
•
• pianeti
•
• asteroidi
COM’È COMPOSTO?
È composto dal e da corpi celesti che orbitano attorno ad esso.
Da 8 pianeti:
COM’È?
• La
È il nostro pianeta, caratterizzato da abbondanza di
e presenza di
COME SI MUOVE?
Gira su se stessa: moto di
(24 ore).
Gira intorno al : moto di rivoluzione
(
giorni e 6 ore)
QUALE SATELLITE HA?
è il satellite della Terra.
Gira su se stessa e intorno alla terra in giorni.

Inquadra il QR code e ascolta il podcast di Pop. Nella sua trasmissione “Scienze in tasca” si parlerà oggi di esplorazioni spaziali. Poi prova a rispondere alle seguenti domande. Se ne hai bisogno, ascolta il podcast più volte.
● Qual è stato il nome del primo satellite artificiale mandato in orbita dalla Terra?
Apollo
Vostok
Sputnik
Voyager
● Chi è stato il primo essere umano a viaggiare nello spazio?
Neil Armstrong
Yuri Gagarin
Laika
Sputnik
● In che anno l’uomo ha compiuto il suo primo sbarco sulla Luna?
1957
1961
1969
2000
Rispondi alle domande usando frasi complete
● Come si chiama il tipo di veicolo robotico che esplora la superficie di Marte, cercando tracce di acqua o vita?
Apollo
Rover
Sputnik
Bip
● Quale delle seguenti non è un’applicazione pratica delle scoperte spaziali che usiamo sulla Terra?
Il GPS
Le previsioni meteo
Le telecomunicazioni
La produzione di acqua
● Quale pianeta o satellite del Sistema Solare vorresti esplorare e perché?
● Quale obiettivo principale daresti alla tua missione (ad esempio: cercare acqua, trovare forme di vita, studiare vulcani, ecc.)?
● Secondo te, in una missione spaziale, quali sono i vantaggi di usare i robot e quali quelli di avere un astronauta a bordo?
Costruiamo il nostro Rover marziano
Lavorando in piccolo gruppo, assemblate con materiali di riciclo (scatole, rotoli di carta, tappi, cannucce) il vostro ‘Rover Marziano’, un veicolo che possa esplorare la superficie di Marte. Il vostro Rover deve avere ruote grandi per superare gli ostacoli e un braccio per raccogliere i campioni. Mostrate il vostro lavoro alla classe e spiegate come lo avete realizzato.
Vi piacerebbe riprodurre in pochi semplici passaggi una costellazione illuminata? Bastano pochi oggetti e un pizzico di pazienza.
COSA FARE?
1 Cercate in rete immagini di costellazioni.
2 Riproducete la costellazione scelta sul cartoncino e fate due buchi distanti circa 2 mm su ogni stella della costellazione.
3 Sul retro del cartoncino, attaccate il nastro di rame lungo le piste rappresentate, facendo attenzione a tagliare il nastro a metà se è troppo largo, perché con un nastro più sottile è più facile realizzare il circuito. Fate attenzione a sovrapporre molto bene i due nastri in corrispondenza dei cambi di direzione, creando delle “X” negli incroci. Le due piste, + e -, non devono toccarsi mai, altrimenti il circuito va in corto e la batteria è da buttare.
4
5
Inserire i piedini dei LED nei due buchi e collegarli, piegandoli, alle due piste di nastro conduttivo, facendo attenzione che il piedino lungo tocchi la pista positiva e quello corto la pista negativa. Fissate i piedini con un piccolo pezzo di nastro. Appoggiate la pila sulla pista +, in corrispondenza dell’angolo del cartoncino.
Piegate il cartoncino lungo la linea tratteggiata e bloccate con una molletta. In questo modo il lato positivo della batteria è adagiato sulla pista positiva e quello negativo è toccato dalla pista negativa. Si dovrebbero accendere tutte le stelle.
6 Se non si accendono alcune stelle, rivedete i collegamenti, in particolare controllate che il piedino lungo del led sia collegato alla pista positiva. Inoltre controllate che non ci sia un corto circuito oppure che la pila non sia capovolta.
COSA SERVE?
● pila a bottone da 3 volt
● nastro di rame con adesivo conduttivo (larghezza 6-8 mm)
● diodi LED bianchi da 3 mm
● puntina per forare il cartoncino
● una molletta/clip
● forbici per tagliare il nastro di rame
● un cartoncino
● matita
● immagini di costellazioni

1 Collega ogni immagine al nome corrispondente.




2 Sottolinea l’alternativa corretta.
● Le galassie/comete sono ammassi di stelle, gas e polveri; quella in cui ci troviamo noi si chiama Terra/Via Lattea
● Per osservare il cielo gli scienziati usano il microscopio/telescopio.
● Il moto apparente del Sole dipende dal moto di rivoluzione/rotazione della Terra.
● La Luna è il pianeta/satellite della Terra.
● Il Sistema Solare comprende otto/nove pianeti.
● Le stelle emettono luce/fiamme e calore.
● La stella più vicina è la Luna/il Sole
● La scienza che studia l’Universo è l’astronomia/astrologia.
3 Scrivi il nome di ogni pianeta al posto giusto.

4 Completa il testo con le seguenti parole: stagioni · la rotazione · un anno · 24 ore · inverno · la rivoluzione · pianeta · un giorno 365 giorni e 6 ore · invertite · emisferi
WANING CRESCENT
La Terra è un del Sistema Solare. Essa compie due movimenti: intorno al proprio asse e
intorno al Sole.
Il primo movimento dura
, corrispondente a
e determina l’alternarsi del dì e della notte. Il secondo movimento dura , corrispondente a , e determina l’alternarsi delle . Esse sono nei diversi : quando nell’emisfero settentrionale è , in quello meridionale è estate e viceversa.
WAXING CRESCENT
QARTER LAST QARTER
5 Collega ogni fase lunare con l’immagine e la propria descrizione.
WANING GIBBOUS
La Luna si nasconde dietro la Terra. Il cielo notturno è più buio.
QARTER
La Luna splende al massimo e illumina la notte sulla Terra.
QARTER
• Ti è piaciuta questa unità?
• Quale argomento ti è piaciuto di più? Perché?
WAXING CRESCENT WAXING GIBBOUS NEW MOON
WANING CRESCENT
MOON
La luce della Luna inizia a diminuire, la falce si prepara a scomparire di nuovo.
WANING GIBBOUS
WAXING GIBBOUS
WANING CRESCENT NEW LAST QARTER
Un sottile spicchio di luce lunare compare nel buio, come una falce d’argento.
MOON
WANING GIBBOUS
• Colora di il quadratino degli esercizi che hai trovato facili e di quello degli esercizi che hai trovato difficili.

L’energia ha la capacità di trasformare le cose intorno a noi. Come dicono gli scienziati, l’energia è la capacità di com piere un lavoro. Può assumere qualsiasi forma e passare dall’una all’altra: le forme di energia possono trasformarsi.

Questa non è solo una deliziosa torta! È una riserva di energia chimica pronta per essere usata. Secondo te, da dove proviene questa energia?

Il ghepardo è la pura espressione dell’energia cinetica. Ogni sua falcata sprigiona la forza potente del movimento. Eppure non funziona a batterie. Quale sarà il suo carburante?




Questa pala eolica è l’esempio perfetto di come poter trasformare il movimento cinetico dell’aria, l’energia eolica, in energia elettrica pulita. Ti sei mai chiesto in che modo?
P RIMA O SSERVO P OI... RIFLETTO

Quando questo motore è acceso, crea energia meccanica: la forza combinata di movimento e posizione che ci permette di viaggiare, lavorare e spostare cose pesanti. Ma cosa serve al motore per funzionare?
Osserva attentamente le immagini. Secondo te, c’è un tipo di energia che può accomunarle tutte? C’è qualcosa nelle immagini che si collega a un oggetto o a una situazione che hai vissuto oggi? Fai un esempio.
In quale delle immagini è rappresentato il modo più pulito per usare o produrre energia e perché?


L’energia può assumere molteplici forme che si modificano e si trasformano l’una nell’altra. Eccone alcune tra le principali.
ENERGIA LUMINOSA
È energia sotto forma di luce emessa da un corpo naturale, come il Sole, o artificiale, come una lampadina.

ENERGIA SONORA
È l’energia trasportata da onde sonore attraverso un mezzo, come l’aria o l’acqua. È prodotta da una fonte sonora, come un altoparlante o un’esplosione. Anche il suono è in grado di compiere un lavoro, per esempio fa vibrare le casse dello stereo.

ENERGIA TERMICA
È l’energia del calore. Il Sole, il fuoco, una lampadina forniscono sia energia termica che energia luminosa.

ENERGIA ELETTRICA
È prodotta dal movimento degli elettroni, piccolissime particelle che si trovano negli atomi. È la forma di energia più utilizzata dall’uomo.

È l’energia dei cibi e dei combustibili, le sostanze che possono bruciare. Per svolgere le nostre attività noi abbiamo bisogno di cibo, così come un motore per funzionare ha bisogno di un combustibile come la benzina.

È l’energia imma gazzinata all’inter no di un oggetto non in movimen to, ma capace di divenire attiva. Una molla compressa possiede energia potenziale che può liberare appena la si lascia libera di espandersi.

SVILUPPO LE COMPETENZE
RIFLETTO E IMPARO
È l’energia dei macchinari in azione, come quella di un motore acceso.

È quella che viene prodotta dalla rottura degli atomi ed è un’energia molto potente.

È l’energia dei corpi in movimento, per esempio quella di una cascata d’acqua che cade da un dislivello o di un atleta impegnato in una prova fisica.

A casa osserva e annota gli oggetti che usano energia, come luci, televisori, frigoriferi e indica da quale fonte proviene (elettricità, gas, ecc.).
● Raggruppa gli oggetti in base alla fonte energetica e condividi il risultato della tua ricerca e le tue osservazioni con la classe.
● Insieme stabilite poi qual è la fonte energetica più utilizzata nelle nostre case.
L’energia non si crea e non si distrugge: cambia solo forma.
Una fonte di energia è dunque qualcosa da cui si può ricavare energia, nel senso che è facile utilizzare o trasformare l’energia che essa possiede. Se si trova disponibile in natura una fonte di energia si dice primaria
Fonti non rinnovabili
Alcune fonti di energia sono dette non rinnovabili perché hanno tempi di rigenerazione lunghissimi. Si sono formate nel corso di milioni di anni, come i combustibili fossili, o addirittura al momento della formazione della Terra, come l’uranio utilizzato per produrre l’energia nucleare. La loro disponibilità, per quanto grande, è limitata: esse costituiscono una sorta di magazzino energetico della Terra, in progressivo esaurimento.
Sono così chiamati perché:
● vengono bruciati per produrre energia;
● si sono formati dalla fossilizzazione di piante e animali preistorici.

È il prodotto della lentissima
trasformazione di sostanze organiche depositate sul fondo di antichi mari o laghi.

Ha un’origine simile a quella del petrolio; infatti spesso un giacimento fornisce sia petrolio sia gas naturale.
SOTTOLINEO
Deriva dalla fossilizzazione di immense foreste; fino alla prima metà del Novecento era la fonte più utilizzata.

Sottolinea nel testo la risposta alle seguenti domande.
● Che cos’è una fonte di energia?
● Che tipo di fonti sono i combustibili fossili?
● Perché si chiamano così?
Fonti rinnovabili
Si chiamano così perché provengono da risorse naturali che si rigenerano nel tempo. Il Sole, il vento, il calore della Terra e l’acqua, se utilizzata in modo sostenibile, sono fonti di energia rinnovabile, disponibili in natura con continuità. Anche la legna viene considerata una fonte rinnovabile purché se ne consumi solo una quantità limitata e si proceda alla riforestazione, laddove sono stati abbattuti gli alberi.
IL SOLE
Il sole è la fonte dell’ ENERGIA
FOTOVOLTAICA . I pannelli fotovoltaici catturano l’energia luminosa del Sole e la convertono in elettricità.

L’ACQUA
L’acqua è la fonte dell’ENERGIA
IDROELETTRICA.
Le centrali idroelettriche sfruttano l’energia cinetica dell’acqua che, da quota elevata, precipita attraverso condutture per produrre elettricità.

STUDIO CON METODO
COMPRENDO E RIELABORO
IL VENTO
Il vento è la fonte
dell’ENERGIA EOLICA.
Le pale dei mulini, le vele delle imbarcazioni e le pale eoliche sono progettate per sfruttare l’energia del vento, detta eolica da Eolo, il nome del dio dei venti degli antichi Greci.

IL CALORE
Il calore è la fonte
dell’ENERGIA
GEOTERMICA.
Nel sottosuolo è presente vapore che si trova a temperature molto elevate; dove possibile, esso viene portato in superficie per produrre elettricità.

Segna con una ✘ la definizione che ritieni corretta e motiva la tua scelta.
● Le fonti primarie: sono utilizzabili dall’uomo direttamente, come si trovano in natura. vengono così chiamate perché hanno primaria importanza per l’uomo.
Spiega la differenza tra fonti primarie rinnovabili e non rinnovabili.
Le fonti di energia secondarie vengono prodotte dall’uomo mediante la trasformazione delle fonti primarie.

Le raffinerie sono impianti di grandi dimensioni.

La plastica è un derivato del petrolio.
I derivati del petrolio
Il petrolio greggio, cioè appena estratto dal sottosuolo, è denso e vischioso. Viene lavorato a temperature elevate nelle raffinerie per poter essere utilizzato sotto forma di:
● benzina, carburante per mezzi di trasporto terrestri (automobili, motociclette, camion) e marini (navi);
● gasolio, carburante per i motori diesel e per gli impianti di riscaldamento tradizionali;
● cherosene, carburante per i motori degli aerei;
● olio combustibile, impiegato nelle centrali per produrre elettricità.
Questi derivati del petrolio sono in grado di bruciare rapidamente, liberando energia termica che a sua volta può essere trasformata in altre forme di energia (meccanica, elettrica). Per questo motivo costituiscono fonti energetiche secondarie di enorme importanza.
PETROLIO E PLASTICA
Il petrolio viene impiegato anche per produrre materie plastiche e fibre sintetiche. Per produrre 1 kg di plastica per alimenti (come quella delle bottiglie per l’acqua) occorrono circa 2 kg di petrolio. È importante imparare a riciclare e smaltire correttamente i prodotti in plastica per ridurre il nostro impatto sull’ambiente e promuovere uno sviluppo sostenibile.
RIELABORO INFORMAZIONI
Spiega la differenza tra fonti di energia primarie e secondarie e fai alcuni esempi per entrambe.
L’energia elettrica è legata alla capacità degli atomi di cedere o acquistare particelle dette elettroni.
Un flusso di elettroni in movimento costituisce una corrente elettrica.
L’energia elettrica si trasporta velocemente attraverso semplici cavi di metallo e si trasforma facilmente.
Per questi due grandi vantaggi è diventata, perciò, fondamentale per la vita dell’uomo: quasi tutti i dispositivi di uso quotidiano, infatti, oggi funzionano con l’energia elettrica. Per questo viene continuamente prodotta nelle centrali elettriche, attraverso l’impiego delle fonti primarie di energia, principalmente quelle fossili e, in misura più limitata, di quelle rinnovabili.

L’energia elettrica si trova anche in natura, per esempio nei fulmini.
SVILUPPO LE COMPETENZE
RIFLETTO E MI CONFRONTO
Rifletti con i compagni e l’insegnante e rispondi.
● Potresti fare a meno dell’energia elettrica?
● In quali aspetti della tua vita risulta indispensabile?

L’energia elettrica è entrata nelle case all’inizio del Novecento.
Il primo a produrla fu, nel 1799, lo scienziato italiano Alessandro Volta.
Egli impilò alternandoli, dischi di metallo (zinco e rame) e di lana inzuppata di acqua e sale, collegati alle estremità da un filo metallico. In questo modo riuscì a generare una debole corrente elettrica che attraversava il filo.
Aveva inventato la prima pila, chiamata così appunto per come era stata costruita.




L’Obiettivo 7 dell’Agenda 2030 è: “Energia rinnovabile”. Questo obiettivo mira a garantire l'accesso universale a servizi energetici moderni, efficienti e sostenibili. L'energia rinnovabile, come l'energia solare, eolica e idroelettrica, è una risorsa fondamentale per raggiungere questo obiettivo. L’esigenza non è solo quella di assicurarsi un’energia “infinita” (le fonti non rinnovabili sono infatti destinate a esaurirsi), ma anche e, soprattutto, quella di avere un’energia “pulita”.
Le fonti non rinnovabili, infatti, sono altamente inquinanti. Quando bruciano, i combustibili fossili rilasciano gas che aggravano l’effetto-serra e il surriscaldamento del pianeta.
Le centrali nucleari producono scorie radioattive e dannose per la salute di tutti i viventi per migliaia e migliaia di anni. Le fonti rinnovabili, invece, non inquinano: sono “verdi”, cioè sono amiche dell’ambiente.
Investire nell'energia rinnovabile non solo aiuta a proteggere il nostro pianeta e la nostra salute, ma crea anche nuovi posti di lavoro e opportunità economiche. Attraverso l'adozione diffusa di energie rinnovabili, possiamo costruire un futuro più verde e sostenibile per tutti.
Intervista un membro della tua famiglia sull’energia rinnovabile, cerca di scoprire cosa sa di essa ed esponi il frutto della tua ricerca alla classe e all’insegnante.
Dopo aver discusso insieme sull’importanza delle energie rinnovabili, create un poster o un breve testo informativo sulla loro importanza e su come poter contribuire alla loro diffusione.
La luce è davvero una forma di energia straordinaria che ci permette di comprendere e interagire con il nostro ambiente in modi affascinanti. Essa è composta da onde che si comportano come raggi rettilinei e viaggia alla velocità di 300000 km al secondo.
I corpi che emettono luce sono chiamati corpi lumino -
si o sorgenti luminose. Sono corpi luminosi il Sole, una candela o una lampadina; da essi infatti partono raggi di luce che si propagano in tutte le direzioni.
I corpi che invece non emettono luce, ma vengono illuminati, si comportano in modo diverso a seconda del materiale di cui sono fatti.
I corpi opachi non lasciano passare la luce; dietro di loro si forma perciò un’ombra.

SVILUPPO LE COMPETENZE
FACCIO ESPERIMENTI
1 Prendi 4 rettangoli di cartoncino, piegane un’estremità a L in modo che stiano dritti, poi sovrapponili e forali. Disponili a 10 centimetri di distanza l’uno dall’altro, dritti e con i buchi allineati, e osserva attraverso i buchi la luce di una candela
2 Ora sposta uno dei cartoncini.
I corpi trasparenti lasciano passare la luce, permettendo di vedere nitidamente ciò che sta dietro di loro.


I corpi traslucidi lasciano passare solo in parte la luce, non permettendo di distinguere nitidamente gli oggetti dietro di loro.



CHE COSA SUCCEDE?
La fiamma non si vede più, perché la luce ha incontrato il cartoncino, che è un corpo ed è stata bloccata. Abbiamo così dimostrato che i raggi di luce viaggiano in linea
RIFLESSIONE
A seconda delle caratteristiche dei corpi che si trovano lungo il cammino della luce, si possono verificare diversi fenomeni.
La luce incontra un corpo opaco con superficie lucida e levigata.
DIFFUSIONE
La luce incontra un corpo opaco con superficie non levigata.
RIFRAZIONE
La luce attraversa due corpi trasparenti, per esempio l’aria e l’acqua.
I raggi rimbalzano sulla superficie in direzione e verso opposti.
I raggi rimbalzano sulla superficie in tutte le direzioni.
Quando incontrano la superficie di separazione dei due corpi, i raggi deviano.
STUDIO CON METODO
LEGGO E COMPRENDO CON L’AIUTO DELLE IMMAGINI
Osserva le fotografie, riconosci il fenomeno luminoso che illustrano e completa le didascalie.

1 2 3

Una cannuccia immersa nell’acqua sembra spezzata per il fenomeno della
La direzione dei raggi luminosi cambia dall’aria all’
La luce del Sole colpisce la superficie dell’acqua e viene come su uno specchio, restituendo l’immagine del panorama intorno.
Per ottenere una luce morbida, i fotografi utilizzano teli e pannelli che la luce delle lampade.


Perché gli oggetti ci appaiono colorati?
La maggior parte dei corpi diffonde la luce, ma non... “tutta” la luce.
La luce del Sole o di una lampadina, infatti, ci sembra bianca, ma in realtà è formata da onde di lunghezze diverse che il nostro occhio percepisce come colori diversi: rosso, giallo, arancione, verde, azzurro, indaco e viola, che sono i sette colori dell’arcobaleno.
Quando la luce colpisce un oggetto, alcuni raggi colorati vengono assorbiti, altri diffusi. Sono questi ultimi a raggiungere il nostro occhio: perciò noi vediamo l’oggetto di un determinato colore.

I corpi rossi assorbono tutti i raggi meno quello rosso.
SVILUPPO LE COMPETENZE
FACCIO ESPERIMENTI
1 Prendi un disco di cartone, dividilo in sette spicchi uguali e colora ciascuno con un colore dell’arcobaleno. Foralo al centro e inserisci nel buco una matita.
2 Ora fai ruotare velocemente il disco.
CURIOSITÀ POP
Quando attraversa corpi con caratteristiche particolari, la luce bianca si separa nei sette colori componenti. Succede attraverso i prismi di vetro e attraverso le minuscole goccioline d’acqua sospese nell’atmosfera dopo un temporale: è così che si forma

luce goccia di pioggia

I corpi neri assorbono tutti i raggi.



I corpi bianchi diffondono tutti i raggi.
CHE COSA SUCCEDE?
Il disco appare di colore
La rotazione, infatti, fa sì che nel nostro occhio i colori risultino mescolati fra loro.

Le corde di una chitarra vibrano e creano un suono: è così che il nostro orecchio percepisce la musica.

La luce viaggia molto più velocemente del suono. Ecco perché vediamo il lampo e dopo sentiamo il tuono!
STUDIO CON METODO
LEGGO E COMPRENDO
Rispondi a voce.
● Che cosa deve sempre fare un corpo per produrre un suono?
● Come si chiama il materiale che permette alle vibrazioni di arrivare fino al nostro orecchio?
● In quale tipo di materia il suono viaggia più velocemente?
Un suono nasce sempre quando un corpo vibra, cioè quando compie un rapido movimento avanti e indietro.
Il corpo che vibra si chiama sorgente sonora. Quando vibra, spinge e tira le particelle che lo circondano, mettendo in movimento l’aria, l’acqua o qualsiasi altro materiale vicino. Questo movimento si diffonde sotto forma di onde acustiche, che viaggiano nello spazio fino a raggiungere il nostro orecchio. Lì vengono trasformate in segnali che il cervello riconosce come suoni.
Perché un suono possa essere ascoltato, deve esserci un mezzo che trasmetta queste vibrazioni dalla sorgente fino a noi. Il mezzo più comune è l’aria, ma anche l’acqua e i solidi possono trasportare molto bene il suono.
Per esempio, se appoggi l’orecchio a un tavolo, puoi sentire più chiaramente i colpi dall’altra parte: significa che il legno sta trasmettendo il suono.
Le onde sonore non viaggiano sempre alla stessa velocità: il loro percorso dipende da come sono organizzate le molecole del materiale in cui si muovono. Nei liquidi e nei solidi, dove le molecole sono più vicine tra loro, le vibrazioni si passano il “messaggio” più in fretta. Per questo il suono si diffonde più velocemente sott’acqua o attraverso un metallo rispetto all’aria.
SVILUPPO LE COMPETENZE
FACCIO ESPERIMENTI
1 Copri una ciotola con pellicola trasparente per alimenti, facendo in modo che sia ben tesa.
2 Spargi sulla pellicola un po’ di zucchero o sale fino.
3 Avvicinati alla ciotola con un tamburello e batti su di esso producendo un forte rumore.
CHE COSA SUCCEDE?
I granelli sulla pellicola rimbalzano. Le prodotte dal suono del tamburello si propagano nell’ facendo la pellicola e rimbalzare i granelli.

Le caratteristiche del suono
Il suono è una forma di energia che ha diverse caratteristiche importanti.
● L’intensità ci dice quanto un suono è forte o debole. Pensa al volume della radio: se lo alzi, aumenta l’intensità del suono. L’intensità dipende dall’ampiezza delle vibrazioni: più sono grandi, più il suono è forte. L’intensità del suono si misura in decibel (dB). Un sussurro è di circa 20 dB, mentre il rumore di un martello pneumatico può arrivare a100 dB ed essere pericoloso per le nostre orecchie!
● Il timbro è ciò che rende un suono unico. Grazie al timbro possiamo riconoscere se una stessa nota è suonata da un pianoforte, da una chitarra o da un violino. È anche grazie al timbro che distinguiamo le diverse voci delle persone: ognuno ha un timbro personale. Il timbro dipende dalla forma dell’onda sonora creata dalla fonte specifica (la cassa armonica del violino, le corde vocali, ecc.).
● L’altezza indica se un suono è acuto (alto) o grave (basso). Il canto di un uccellino è molto acuto, mentre il rumore di un camion è grave. L’altezza dipende dalla velocità delle vibrazioni, cioè da quante oscillazioni (vibrazioni) l’onda sonora compie in un secondo. Si misura in Hertz (Hz). Più la frequenza è alta, più il suono è acuto.
Le onde sonore rimbalzano
Quando le onde sonore incontrano un ostacolo duro, come una parete di roccia o il muro di una grande caverna, rimbalzano e tornano indietro. Questo ritorno del suono si chiama eco. È lo stesso effetto che si può sentire nelle montagne o in una stanza molto grande e vuota: la nostra voce sembra ripetersi dopo un attimo. Se le pareti sono molto vicine, il suono che rimbalza torna così velocemente che si sovrappone al suono originale. Questo crea un effetto di prolungamento e confusione che chiamiamo rimbombo o riverbero.
STUDIO CON METODO
COLLEGO E IMPARO
Collega ogni parola alla caratteristica corretta.
Ritorno del suono dopo che ha colpito una superficie dura.
Indica se un suono è forte o debole.

L’altezza sonora di questa balena è unica. Emette suoni molto bassi, appena superiori alla nota più bassa di una tuba.
Permette di distinguere strumenti e voci diverse.
Indica se un suono è acuto o grave.
L’ENERGIA
L’energia è la capacità di un corpo di compiere un lavoro, cioè di produrre un movimento o una trasformazione della materia. L’energia si presenta sotto molte forme (luminosa, sonora, termica, elettrica, potenziale, cinetica, meccanica, chimica, nucleare...) che si modificano e trasformano l’una nell’altra.
LE FONTI DI ENERGIA

Le fonti di energia primarie sono presenti in natura, le fonti secondarie sono derivate dalle primarie e prodotte dall’uomo.
Le fonti primarie sono:
• non rinnovabili, come i combustibili fossili (petrolio, carbone, gas metano) e l’uranio, sono limitate e inquinanti;
• rinnovabili come il Sole, il vento, l’acqua e il calore della Terra, si rigenerano e sono pulite.
Le fonti secondarie sono i combustibili derivati dal petrolio e la corrente elettrica
L’ENERGIA DELLA LUCE
La luce è una forma di energia, prodotta da corpi luminosi, come il Sole, e si propaga in linea retta anche nel vuoto.
La luce bianca è composta da sette raggi corrispondenti ai colori dell’arcobaleno. I corpi illuminati possono essere trasparenti, opachi o traslucidi e, a seconda della loro superficie, possono riflettere o diffondere la luce. Il loro colore dipende dai raggi che diffondono.
L’ENERGIA DEL SUONO
Il suono è una forma di energia, prodotta dalle vibrazioni di un corpo.
Si propaga sotto forma di onde sonore attraverso un mezzo.
Le sue caratteristiche sono altezza, timbro e intensità.
La sua intensità si misura in decibel

Completa la mappa con l’aiuto delle parole chiave evidenziate nella pagina a fianco. Poi utilizzala per esporre a voce l’argomento.
L’ENERGIA
CHE COS’È?
È la capacità di un lavoro.
COME SI MUOVE?
Si presenta sotto molte
che si modificano e l’una nell’altra.
CHE COS’È?
Illumina corpi che la possono o diffondere.
COME PUÒ ESSERE?
Primarie: Non , come .................................... , come ....................................................
Secondarie: come
QUALI FENOMENI PRODUCE?
È l’energia prodotta da corpi e si propaga in linea . È composta da .............................................................. raggi.
L’ENERGIA DEL SUONO
CHE COS’È?
È l’energia prodotta dalle di un corpo.
Si propaga sotto forma di
QUALI CARATTERISTICHE HA?
• Intensità
• Altezza
• Si misura in


Inquadra il QR code e ascolta il podcast di Pop. Nella sua trasmissione “Scienze in tasca” si parlerà oggi dell’obiettivo 7 dell’Agenda 2030: energia pulita e accessibile per tutti. Poi prova a rispondere alle seguenti domande. Se ne hai bisogno, ascolta il podcast più volte.
● Che cosa vuole ottenere l’Obiettivo 7 dell’Agenda 2030?
Costruire più fabbriche
Energia pulita e accessibile per tutti
Aumentare l’uso del carbone
Spegnere tutte le luci del mondo
● Quale fonte non è un’energia rinnovabile?
Sole Vento
Carbone Acqua
● Perché alcune fonti di energia inquinano?
Perché usano materiali che bruciano e producono fumo
Perché sono troppo rumorose
Perché funzionano solo di notte
Perché costano troppo
● Cosa possiamo fare per ridurre gli sprechi?
Lasciare le luci accese
Usare molti elettrodomestici insieme
Spegnere ciò che non serve
Tenere i caricabatterie sempre attaccati
● Cosa significa che una fonte di energia è rinnovabile?
Che si può usare solo una volta
Che non inquina
Che produce molto rumore
Che non si esaurisce mai, perché si rigenera continuamente
● Quale elemento naturale viene utilizzato per produrre energia eolica?
Il calore della Terra
.Il movimento dell’acqua
Il Sole
Il vento, grazie alle pale eoliche
Indica se le seguenti affermazioni sono Vere (V) o False (F).
Le energie rinnovabili non si esauriscono mai.
Le turbine eoliche funzionano grazie al sole.
In alcune parti del mondo manca ancora l’energia elettrica. V F
Risparmiare energia è utile solo per le famiglie, non per il pianeta. V F
L’energia prodotta dal sole non inquina l’aria. V F
FORNO SOLARE. In coppia, costruite un piccolo forno solare usando una scatola di cartone, carta stagnola e pellicola trasparente. Osservate come il calore del sole può scaldare o sciogliere piccoli alimenti, come un pezzetto di cioccolato. Registrate le vostre osservazioni.
Vuoi imparare a creare una pila fatta con un limone? Segui questi semplici passaggi e potrai costruire la tua pila in pochi minuti! Divertiti a sperimentare, è un ottimo modo per imparare i principi di base dell’elettricità, in modo pratico e divertente.
COSA FARE?
1 Facendoti aiutare da un adulto, infila un chiodo e un filo di rame in ogni limone.
2 Collega il filo di rame del primo limone con il chiodo del secondo limone. In questo modo resteranno un chiodo e un filo di rame “liberi”. Il filo di rame e il chiodo liberi non devono toccarsi, altrimenti causerebbero un corto circuito!
3 Per accendere la lampadina appoggia una delle due gambette, della lampadina a diodi, al chiodo libero e l’altra al filo di rame libero. La lampadina dovrebbe illuminarsi!
4 Ora hai costruito la tua pila di limone! Ricorda che la pila di limone produrrà una corrente elettrica, ma non durerà a lungo. Quando il limone inizierà a seccarsi, dovrai sostituirlo con uno nuovo per continuare a usare la pila.


COSA SERVE?
● Due limoni
● Filo di rame
● Due chiodi zincati

Se la lampadina non si accende al primo colpo, prova ad adottare questi accorgimenti:
● assicurati che stai usando un LED rosso. La “batteria a limoni” è piuttosto debole paragonata a batterie comuni e i LED rossi hanno bisogno di batterie meno potenti rispetto a quelle di altri colori.
● Inverti il senso della lampadina: il primo diodo sul filo di rame e il secondo sul chiodo.
● Utilizza più limoni o taglia i tuoi due limoni a pezzi e collegali utilizzando altri chiodi e pezzi di filo di rame. Collegando delle batterie deboli in serie ottieni un maggior voltaggio e quindi un maggior flusso di corrente. Più corrente rende il LED più luminoso. Attenzione però a non esagerare, se la corrente è troppo forte il LED si rompe!
1 Rispondi alle seguenti domande.
● Che cos’è l’energia?
● Sai elencare almeno tre tipi di energia?
● Che cos’è l’energia cinetica?
● Qual è la differenza tra fonti primarie e secondarie?
● E tra fonti rinnovabili e non rinnovabili?
2 Quali forme di energia sono rappresentate? Scrivi il numero corrispondente.



4. Energia chimica
5. Energia termica
6. Energia cinetica



3 Osserva l’immagine del Sole. Quali tipi di energia ti vengono in mente?

4 Indica con una ✘ se ogni affermazione è vera (V) o falsa (F).
● La luce si trasmette nel vuoto. V F
● La luce non può compiere nessun lavoro. V F
● L’energia luminosa può essere ricavata dall’energia cinetica. V F
● La rifrazione è la deviazione di un raggio luminoso che attraversa due corpi trasparenti. V F
● La riflessione è un fenomeno che possiamo osservare negli specchi. V F
● I corpi bianchi assorbono tutti i raggi di luce. V F
● Un corpo rosso assorbe tutti i raggi colorati della luce tranne il rosso. V F
● Un corpo rosso assorbe il raggio colorato rosso e diffonde i raggi degli altri colori. V F
● I corpi opachi formano ombre. V F
5 Collega i termini alla loro spiegazione.
decibel
Una delle caratteristiche del suono
Insieme degli effetti negativi prodotti dai rumori
Unità di misura dell’intensità dei suoni
Riflessione del suono contro un ostacolo
Corpo che emette il suono
• Ti è piaciuta questa unità?
• Quale argomento ti è piaciuto di più? Perché? ....................................................................................................
• Colora di il quadratino degli esercizi che hai trovato facili e di quello degli esercizi che hai trovato difficili.

Il corpo umano è composto da molti sistemi e apparati diversi che lavorano insieme in armonia e ci permettono di crescere, vivere e affrontare la vita ogni giorno. Ogni parte del corpo ha una funzione specifica.
A cosa serve lo scheletro? Da cosa è formato?



Il cuore pompa il sangue a tutto il corpo. Secondo te, perché non deve mai smettere di battere?



Il cervello controlla tutto ciò che facciamo.
Sai dire in che modo?
METODO P O P






P RIMA O SSERVO P OI... RIFLETTO



































I polmoni ci permettono di respirare. A cosa somigliano?
Osserva le immagini. Sai che rappresentano solo una piccola parte del nostro corpo. pensi che un organo sia più importante di un altro? Se sì, quale e perché? Discutine con l’insegnante e la classe.

L’essere umano possiede alcune caratteristiche che sono comuni anche ad altri animali. Come tutti i vertebrati, ha uno scheletro che sostiene il corpo. Come tutti i mammiferi, è omeotermo e viviparo: la sua temperatura corporea si aggira costantemente intorno ai 37 °C e i neonati nascono già formati e vengono nutriti dal latte della mamma.
Il corpo umano, però, presenta caratteristiche evidenti che lo differenziano dagli altri animali:
● le mani si sono specializzate per affrontare numerosi compiti;
● i piedi si sono modificati per sostenere il peso del corpo eretto in movimento;
● il cervello, in proporzione al corpo, è più grande di quello di qualunque altra specie animale;
● la pelle umana è molto diversa da quella di altri animali. La maggior parte di noi non ha il corpo coperto di peli come i mammiferi.
La scienza che studia il corpo dei viventi, e in particolare dell’uomo, è l’anatomia
CURIOSITÀ POP
L’UOMO VITRUVIANO DI LEONARDO DA VINCI
Leonardo da Vinci (1452-1519), scienziato, inventore e pittore, fu affascinato dall’anatomia e applicò il suo talento in centinaia di disegni. Scrisse: “Per analizzare il corpo è impossibile che gli scrittori ne possano dare vera notizia. Questa mia figurazione ti mostrerà come se tu avessi l’uomo naturale davanti agli occhi.”
STUDIO CON METODO
COMPRENDO E RIELABORO
Rispondi alle domande.
● Quali caratteristiche accomunano l’essere umano agli altri mammiferi?
● Quali sono le differenze?
● Quale scienza studia il corpo umano?
Il corpo umano è formato da migliaia di miliardi di cellule, tutte collegate insieme.
Le cellule sono troppo piccole per essere osservate a occhio nudo: si possono studiare solo con l’aiuto dei microscopi. Grazie a essi gli scienziati hanno scoperto che esistono diversi tipi di cellule, con forme molto differenti. Ogni tipo di cellula, infatti, è specializzata nello svolgimento di un preciso compito
Le cellule del cervello, per esempio, sono ramificate per comunicare tra loro, mentre quelle dell’intestino sono piatte per formare un rivestimento. Alcune cellule vivono quanto l’individuo di cui fanno parte, altre solo poche ore, ma sono in grado di riprodursi rapidamente. Quando si riproducono, le cellule si dividono in due, creando una copia di se stesse. Nel nucleo della nuova cellula, in particolare, vi è una copia di una molecola chiamata DNA: essa contiene “l’identikit” dell’individuo e “la ricetta” per il suo sviluppo.
CURIOSITÀ POP
DUE MICROSCOPI
Il microscopio ottico, inventato alla fine del XVI secolo, permette di osservare l’interno delle cellule, ma fornisce immagini piatte. All’inizio del XX secolo è stato inventato il microscopio elettronico, che offre immagini tridimensionali; esso, tuttavia, non consente di visualizzare l’interno delle cellule.
Cellule del sangue fotografate con il microscopio ottico

del sangue fotografate con il microscopio elettronico
STUDIO CON METODO
SOTTOLINEO E IMPARO
Sottolinea nei testi le caratteristiche delle cellule che formano ogni tessuto.
TESSUTO MUSCOLARE
Le cellule che svolgono lo stesso compito formano un tessuto.
Nel corpo umano è possibile distinguere quattro tipi fondamentali di tessuti.
Le sue cellule hanno la capacità di contrarsi, cioè di compiere movimenti. I muscoli possono essere volontari, cioè governati dalla nostra volontà (come quelli utilizzati per correre o ridere), oppure involontari (come quelli che pompano il sangue).

TESSUTO NERVOSO
È formato da cellule dette neuroni che possiedono la caratteristica di reagire agli stimoli ed elaborare risposte, per esempio farci compiere movimenti volontari.
I neuroni presentano una forma caratteristica con numerosi filamenti.

TESSUTO EPITELIALE
È formato da strati di cellule che rivestono e proteggono ogni organo, ogni cavità interna e la superficie esterna del corpo. La pelle è costituita da strati di cellule epiteliali.

TESSUTO CONNETTIVO
Il suo compito è quello di tenere uniti, sostenere e proteggere gli altri tre tipi di tessuti. Le sue cellule hanno forme molto diverse. Le ossa sono formate da tessuto connettivo. Il sangue è un tessuto connettivo liquido.
Il tessuto connettivo adiposo (quello mostrato nella foto) è composto da cellule ricche di grassi che formano uno strato sotto la pelle.

Insiemi di tessuti differenti formano gli organi. Ogni organo svolge una determinata attività.
Gli organi sono raggruppati in sistemi o apparati, ciascuno dei quali è responsabile di una determinata funzione. Sistemi e apparati collaborano tra loro per mantenere in vita l’organismo.
Considera, per esempio, i movimenti del corpo: camminare, saltare, afferrare oggetti, masticare, suonare uno strumento musicale o, semplicemente, stare in piedi, sono tutti possibili grazie all’apparato locomotore.
Sistema: è costituito da uno stesso tessuto.
Apparato: è costituito da sistemi differenti.

Atleti di ogni disciplina dimostrano le immense potenzialità del corpo umano e dell’apparato locomotore.
APPARATO LOCOMOTORE

SISTEMA SCHELETRICO
Ossa e muscoli collaborano formando l’apparato locomotore, che svolge il compito di sostenere il corpo e permetterne i movimenti.
Le ossa sono composte da un particolare tessuto connettivo.
Tutte le ossa del corpo formano sistema scheletrico
STUDIO CON METODO
COMPRENDO E RIELABORO
Rispondi osservando lo schema e rileggendo i testi.
SISTEMA MUSCOLARE

I muscoli sono formati da tessuto muscolare. I muscoli che rivestono le ossa formano il sistema muscolare
● Quali compiti ha l’apparato locomotore? Da che cosa è formato?
Lo scheletro di un essere umano adulto è formato da 206 ossa di forme e dimensioni molto diverse, disposte simmetricamente su entrambi i lati del corpo.
Esse costituiscono una struttura solida e flessibile che svolge diversi compiti:
● dà sostegno e forma al corpo;
● fornisce protezione agli organi vitali interni;
● permette il movimento, insieme al sistema muscolare.
Lo scheletro si può suddividere in tre parti: TESTA, TRONCO e ARTI.
La testa comprende:
• la scatola cranica, che racchiude e protegge il cervello;
• le ossa che costituiscono lo scheletro del volto
Il tronco comprende:
• la colonna vertebrale, formata da 33 ossa, dette vertebre, che insieme rendono flessibile la struttura;
• la gabbia toracica, formata da 12 paia di costole che si uniscono, in parte, nello sterno, un osso disposto verticalmente nel petto;
• il bacino, formato da ossa larghe e piatte, unite tra loro, e posto alla base della colonna vertebrale.
Gli arti sono distinti in:
• arti superiori, con ossa del braccio, dell’avambraccio e della mano;
• arti inferiori, con ossa della coscia, della gamba e del piede.

Pur essendo solide e robuste, le ossa sono sorprendentemente leggere e dotate di flessibilità. Ciò è dovuto al particolare tessuto connettivo di cui sono fatte, costituito da:
● sali minerali, contenenti soprattutto calcio, che rendono l’osso duro;
● osseina, una sostanza che rende l’osso elastico.
All’interno delle ossa è contenuta una sostanza grassa e morbida, il midollo osseo, che produce cellule del sangue. Le ossa sono principalmente di tre tipi.
OSSA LUNGHE
Sono quelle degli arti, più lunghe che larghe.

OSSA CORTE
Presentano lunghezza e larghezza pressoché uguali, come ad esempio le vertebre.
CURIOSITÀ POP
Durante lo sviluppo, l’osseina consente la crescita e l’allungamento delle ossa, garantendo la corretta struttura scheletrica. Con l’avanzare dell’età, la produzione di osseina diminuisce, rendendo le ossa meno flessibili e più fragili.
OSSA PIATTE

Le articolazioni sono i punti in cui le ossa si incontrano. Sono così classificate:
ARTICOLAZIONI MOBILI
Sono sottili strati di tessuto osseo compatto, come la sca pola e l’osso della spalla.

ARTICOLAZIONI SEMIMOBILI E FISSE

Consentono i movimenti. Le superfici ossee in contatto scivolano l’una sull’altra grazie al liquido sinoviale, che agisce da lubrificante. Sono articolazioni mobili quelle delle mani, dei piedi, del ginocchio e della spalla . Quest’ultima è una delle più mobili e complesse del corpo.
STUDIO CON METODO
LEGGO E COMPRENDO
Indica con una ✘ le affermazioni corrette. Le ossa sono formate da sali minerali e osseina.
L’osseina rende le ossa fragili.
Consentono movimenti limitati oppure non permettono nessun movimento. Sono articolazioni semimobili quelle delle vertebre che si trovano alla base del collo . Sono articolazioni fisse quelle delle ossa del cranio, che si saldano fra loro durante la crescita.
Le articolazioni consentono i movimenti.

Il liquido sinoviale rallenta i movimenti.

MUSCOLI SCHELETRICI
Sono i muscoli attaccati alle ossa attraverso i tendini. Permettono il movimento volontario del corpo, come camminare, correre e sollevare oggetti.

STUDIO CON METODO
SCHEMATIZZO E IMPARO
Il sistema muscolare è una complessa rete di muscoli che permettono:
● il movimento e il funzionamento del corpo umano;
● il mantenimento della postura e dell’equilibrio;
● la produzione di calore corporeo;
● la protezione degli organi interni.
Esso è composto da tre tipi di muscoli:
MUSCOLI LISCI
Sono muscoli involontari, come quelli presenti nelle pareti degli organi interni. Essi permettono il funzionamento automatico di molti processi fisiologici.

MUSCOLO CARDIACO
È un muscolo striato e involontario, responsabile della contrazione ritmica del cuore per pompare il sangue nell’organismo.

Scrivi nei cartellini quale tipo di muscolo è rappresentato. Esponi le caratteristiche di ciascuno.

LEGGO E COMPRENDO
Quali tra i seguenti non sono compiti del sistema muscolare? Segna con una ✘
Garantire postura e equilibrio
Trasmettere informazioni al cervello
Permettere il movimento
Favorire la riproduzione delle cellule
I muscoli scheletrici sono formati da fibre muscolari che si contraggono e si rilassano in risposta agli stimoli nervosi, permettendoci di muoverci.
Quando i muscoli si contraggono, essi esercitano una trazione sulle ossa, causando il movimento delle articolazioni. I muscoli sono attaccati saldamente alle ossa attraverso i tendini, “cordoni” robustissimi che possono essere lunghi fino a 40 cm.
Vediamo ora più da vicino come avviene il movimento. Osserva nelle immagini il modo in cui l’azione coordinata di due muscoli produce il movimento del braccio.


Il muscolo A si gonfia, si contrae e quindi si accorcia, tirando l’osso a cui è collegato. In questo modo la mano si avvicina al corpo (movimento di flessione).
Nello stesso momento, il muscolo B si rilassa e si allunga.
Se vogliamo allontanare la mano dal corpo (movimento di estensione), invece, è il muscolo B che si contrae. In questo caso, il muscolo A si distende.

STUDIO CON METODO
LEGGO E COMPRENDO
Rispondi alle domande.
● Quali sono i movimenti che compiono i muscoli?
● Come si chiamano i “cordoni” che collegano i muscoli alle ossa?
Come vedi, i muscoli lavorano in coppia: quando uno si contrae l’altro si rilassa e viceversa. Poiché compiono azioni contrarie, i due muscoli sono detti antagonisti. Possiamo perciò dire che i movimenti volontari sono effettuati dal lavoro combinato di muscoli antagonisti.
● Perché i muscoli lavorano in coppia?
Le ossa costituiscono lo scheletro , una struttura solida e robusta, ma sono leggere e dotate di una certa flessibilità che le protegge da eventuali colpi.
Le ossa sono formate da un tessuto vivo, capace di rinnovarsi. Dopo una frattura presentano una sorprendente capacità di rigenerazione. In un adulto il processo di riparazione di un osso lungo della gamba o del braccio dura circa sei settimane, nei bambini i tempi sono minori.
orbita oculare
ossa dell’avambraccio
ossa della mano
mandibola
scapola
omero
radio ulna
ossa carpali
ossa metacarpali
falangi
ossa della gamba
femore perone
tibia
mascella gabbia toracica
sterno
colonna vertebrale
pelvi
ossa tarsali
ossa metatarsali
falangi
ossa del piede
Se lo scheletro non fosse fornito di muscoli , si ridurrebbe a un groviglio di ossa, come una marionetta senza fili. Sono i muscoli scheletrici a rendere possibile il movimento. Le loro dimensioni possono variare moltissimo. I più piccoli sono responsabili del movimento degli occhi, i più grandi sono i muscoli della schiena e della coscia. Nel loro insieme rappresentano circa il 40% del peso del corpo.
sternocleidomastoideo deltoide bicipite
obliquo esterno dell’addome
quadricipite


grande gluteo medio gluteo
Polmoni
L’apparato respiratorio ci permette di respirare. Attraverso esso il corpo preleva l’ossigeno dall’aria e cede ad essa le scorie. L’apparato respiratorio comprende:
● i POLMONI, posti nella gabbia toracica, dove avvengono gli scambi gassosi tra il corpo e l’ambiente esterno;
● le VIE RESPIRATORIE, che collegano i polmoni all’ambiente esterno e sono costituite dal naso, dalla bocca, dalla faringe, dalla laringe, dalla trachea e dai bronchi.

STUDIO CON METODO
SCHEMATIZZO E IMPARO
Bronchioli

La faringe collega il naso e la bocca con la laringe.
La laringe, a forma di imbuto rovesciato, ospita le corde vocali.
La trachea è un tubo lungo circa 12 cm costituito da anelli. Verso il basso si biforca nei bronchi, che diventano sempre più sottili e si ramificano nei bronchioli
I polmoni, spugnosi e leggeri, sono formati da una miriade di piccole cavità, gli alveoli polmonari, collegati ai bronchioli. Ogni alveolo ha la forma di un piccolissimo acino d’uva.
Nell’immagine evidenzia: di i nomi degli organi che fanno parte delle vie respiratorie; di i nomi delle parti che compongono i polmoni.
Completa lo schema.
Apparato
vie respiratorie polmoni
La respirazione è la funzione che ci permette di immettere ossigeno nel corpo e di rimuovere l’anidride carbonica.
Questo processo è essenziale per la produzione di energia nelle cellule e per eliminare i prodotti di scarto. Comprende due fasi: inspirazione ed espirazione.
Inspirazione: l’aria entra nei polmoni
L’aria che entra nelle cavità nasali o nella bocca viene riscaldata e inumidita. Attraversa la faringe, la laringe e la trachea, entra in canali sempre più ramificati, i bronchi e i bronchioli, che la immettono nei polmoni. Negli alveoli polmonari avviene lo scambio di gas. Ogni alveolo è circondato da una rete di piccoli vasi sanguigni: il sangue cattura l’ossigeno e cede l’anidride carbonica.
Espirazione: l’aria esce dai polmoni
L’aria, carica di anidride carbonica, percorrendo il cammino inverso, fuoriesce dal naso o dalla bocca.
STUDIO CON METODO
LEGGO E COMPRENDO
Ricerca nel testo e rispondi alla seguente domanda.
● Nella respirazione, dove e come avviene lo scambio di gas?
SVILUPPO LE COMPETENZE
RIPRODUCO MODELLI
In gruppo, costruite un modellino dell’apparato respiratorio come nell’immagine. Vi serviranno carta, matite, forbici, nastro adesivo, due cannucce e due palloncini. Soffiate poi nelle cannucce. Quando l’aria entrerà nei palloncini, si dilateranno come fanno i polmoni durante l’inspirazione. Al contrario, lasciando uscire l’aria, i palloncini si sgonfieranno come fanno i polmoni quando espiriamo.
Inspirazione



Per vivere, il nostro corpo ha bisogno di energia, che assume attraverso il cibo. Per fare ciò, il cibo viene trasformato e scomposto in sostanze più semplici. La digestione è l’insieme dei processi che il cibo ingerito subisce nell’apparato digerente.
Quest’ultimo è costituito dal tubo digerente e da diverse ghiandole.
● Il tubo digerente, lungo circa 7 metri, comprende la bocca, l’esofago, lo stomaco, l’intestino tenue e l’intestino crasso.
● Le ghiandole sono: le ghiandole salivari, quelle dello stomaco, il fegato, il pancreas, la cistifellea; si tratta di organi che producono sostanze utili alla scomposizione del cibo.
Il tubo digerente inizia dalla bocca, in cui sono contenuti i denti, la lingua e le ghiandole salivari.
L’esofago collega la gola allo stomaco.
Lo stomaco è una sacca dalle pareti elastiche, composte da tessuto muscolare, e ricche di ghiandole.
STUDIO CON METODO
SCHEMATIZZO E IMPARO
Nell’immagine evidenzia: di i nomi degli organi del tubo digerente; di i nomi delle ghiandole utili al processo digestivo. Completa lo schema.
Fegato

Cistifellea Pancreas
tubo digerente
L’intestino tenue è un tubo lungo circa 5 metri, avvolto in spirali. La sua superficie è ricoperta da cellule epiteliali simili a piccolissime dita, i villi, che assorbono le sostanze utili.
L’intestino crasso è lungo circa 1 metro e mezzo, ha pareti spesse ed è diviso in tre parti: cieco, colon e retto.
Apparato digerente ghiandole
Comprende: Sono:
I denti hanno il compito di masticare il cibo per prepararlo alla digestione. Poiché l’essere umano è onnivoro, i denti hanno forme diverse in base alla funzione che devono svolgere.
● Gli incisivi sono affilati e sono simili a scalpelli per poter tagliare e trattenere il cibo.
● I canini, più lunghi e appuntiti, servono a lacerare.
● I premolari presentano una doppia cresta adatta a triturare.
● I molari, posti in fondo alla bocca, sono i denti più grandi. Come i premolari, sono adatti a triturare i cibi. Benché diversi, i denti presentano la stessa struttura: una morbida polpa circondata da una robusta corazza.
Lo smalto è la sostanza dura e insensibile che riveste la corona, la parte del dente che fuoriesce dalla gengiva.
La dentina è formata da tessuto osseo resistente, ma è più tenera dello smalto. Dà sostegno alla corona e riveste la cavità dove è posta la polpa.
La polpa contiene le terminazioni nervose e i vasi che trasportano il sangue.
Le radici possono essere due o quattro. Fissano il dente all’osso della mandibola o della mascella.

Incisivi
SVILUPPO LE COMPETENZE
OSSERVO E RIFLETTO
Davanti a uno specchio riconosci i tuoi denti incisivi, canini, premolari e molari.
CURIOSITÀ POP
DENTI DA LATTE E DENTI PERMANENTI
I primi denti, detti da latte, compaiono tra il 5° e il 6° mese di vita. Verso i 3 anni i denti sono 20. Tra i 7 e i 14 anni compaiono i denti permanenti (definitivi), che provocano la caduta dei denti da latte. La dentatura di un adulto comprende 32 denti, poiché ai 20 iniziali si aggiungono 8 molari e 4 denti del giudizio (non sempre presenti).

Possiamo schematizzare il percorso del cibo attraverso l’apparato digerente in quattro fasi.
I denti tagliano, lacerano, triturano il cibo, che viene intriso di saliva.
Gli elementi chimici presenti nella saliva agiscono sugli amidi (sostanze presenti nella pasta, nel pane, nel riso) per trasformarli in molecole più semplici. Il cibo, così modificato, prende il nome di bolo ed è sospinto nell’esofago.
FASE 3: NELL’INTESTINO TENUE
Il chimo entra nell’intestino tenue, dove vengono assorbiti quasi tutti i componenti utili presenti nel cibo. Altre sostanze prodotte dal pancreas e dal fegato completano il processo di scomposizione. Il cibo è trasformato in un liquido lattiginoso che prende il nome di chilo.
Le contrazioni dell’esofago spingono il bolo nello stomaco, dove esso rimane per alcune ore. Rimescolato dai movimenti di questo organo e trasformato dai succhi gastrici, che sono acidi potenti, il bolo si riduce a un liquido denso detto chimo.
FASE 4: NELL’INTESTINO CRASSO
Il chilo viene inviato nell’intestino crasso, che ha il ruolo di assorbire parte dell’acqua ancora presente. Infine le scorie rimanenti vengono eliminate ed espulse all’esterno del corpo, attraverso l’ano, sotto forma di feci.
STUDIO CON METODO
COMPRENDO E RIELABORO
Descrivi il percorso del cibo nell’apparato digerente, usando i seguenti termini: stomaco, intestino, fegato, pancreas, esofago, villi intestinali, ano, saliva, denti.
Le scorie solide prodotte dalla digestione vengono espulse dall’apparato digerente, quelle liquide vengono eliminate attraverso l’apparato urinario che filtra il sangue e produce l’urina, un fluido costituito dalle sostanze indesiderate e dall’acqua in eccesso. L’apparato urinario è formato da diversi organi.
I reni, due organi a forma di fagiolo, situati ai lati della colonna vertebrale, svolgono il compito di ripulire il sangue dalle scorie. La vescica è un organo cavo in cui viene immagazzinata l’urina.

Come funzionano i reni
Gli ureteri collegano i reni alla vescica.
L’uretra è un sottile tubo attraverso cui l’urina viene espulsa all’esterno del corpo.
Le pareti interne del rene sono occupate da un sistema di tubicini sottilissimi avvolti su loro stessi, chiamati nefroni. La lunghezza complessiva dei nefroni è sbalorditiva: 80 km! Attraverso di essi passano ogni giorno, per essere filtrati e depurati, circa 180 litri di sangue.
STUDIO CON METODO
LEGGO E COMPRENDO
Per ogni organo scrivi il suo compito:
● reni:
● ureteri:
● vescica:
● uretra:

1,4 miliardi di adulti sono in sovrappeso
L’Obiettivo 3 dell’Agenda 2030 ha come scopo garantire il benessere e una vita sana a più persone possibile, di tutte le età e in ogni parte del mondo. Avere una buona salute è necessario per vivere bene: per studiare, lavorare, occuparsi della casa e della famiglia, per avere una buona qualità della vita. È quindi importante prevenire e curare le malattie, nutrirsi bene, non vivere in un ambiente inquinato.
La FAO (Food and Agriculture Organization of the United Nations – Organizzazione delle Nazioni Unite per l’alimentazione e l’agricoltura) è un’organizzazione che si occupa di accrescere i livelli di nutrizione, aumentare la produttività agricola, migliorare la vita delle popolazioni rurali e contribuire alla crescita economica mondiale (www.fao.org).
Ma qual è il livello di malnutrizione presente al mondo? Innanzitutto bisogna chiarire che la malnutrizione può essere denutrizione o sovralimentazione. La denutrizione è una condizione di malnutrizione dovuta alla mancanza di proteine, vitamine e sali minerali necessari a un organismo. Ancora oggi, al mondo, ci sono 730 milioni di persone che soffrono di denutrizione e che non sono in grado di procurarsi il cibo necessario per una vita adeguata. Tra queste, oltre 200 milioni sono bambini sotto i 5 anni. La denutrizione colpisce i Paesi in via di sviluppo.
La sovralimentazione, invece, è una condizione di malnutrizione dovuta a un consumo eccessivo di grassi, calorie, zucchero, sale. Nei Paesi industrializzati il problema dell’obesità, cioè di un aumento eccessivo del peso e del grasso corporeo, è sempre più diffuso.
730 milioni
di persone sono sottonutrite
2 miliardi di persone sono prive di vitamine e minerali essenziali per una buona salute

Alimentarsi correttamente è fondamentale per salvaguardare la propria salute. Non bisogna mangiare né troppo, né troppo poco (equilibrio quantitativo) e bisogna variare la propria dieta fornendo all’organismo tutti i nutrienti di cui necessita (equilibrio qualitativo). Un buon modo per ottenere questo risultato è regolare la propria alimentazione tenendo conto della cosiddetta piramide alimentare, che suggerisce quali cibi consumare e con quale frequenza. Consultala con attenzione e scopri se la tua dieta è adeguata!
Gli alimenti alla base della piramide alimentare, come pane, pasta, riso, cereali, frutta e verdura, dovrebbero essere consumati quotidianamente per garantire un’alimentazione equilibrata.
Le proteine, invece, vanno assunte variando le fonti, alternando carne, pesce, uova, legumi e formaggi. Gli alimenti al vertice della piramide, come dolci e grassi, dovrebbero essere consumati con moderazione.


grassi e zuccheri aggiunti
SVILUPPO LE COMPETENZE
RIFLETTO E MI CONFRONTO
● Segui una dieta corretta?
● Pensi di dover cambiare qualche abitudine? Rifletti, poi confronta le tue risposte con quelle dei tuoi compagni e insieme scrivete quali sono, secondo voi, le buone regole da seguire per una sana alimentazione.
Il corpo umano è formato da cellule con forme e compiti differenti. Gruppi di cellule uguali formano i tessuti che costituiscono gli organi. Gli organi sono raggruppati in sistemi o apparati che svolgono funzioni diverse e collaborano tra loro.
L’APPARATO LOCOMOTORE
Consente al corpo la postura eretta e il movimento. Comprende il sistema scheletrico e il sistema muscolare. Il sistema scheletrico è formato da ossa, formate da sali minerali e osseina, e articolazioni. Il sistema muscolare è formato dai muscoli, che permettono i movimenti e il funzionamento degli organi interni.
L’APPARATO DIGERENTE
Svolge la digestione, cioè il processo di trasformazione e assorbimento del cibo da cui il nostro corpo ricava l’energia per vivere.
La digestione inizia nella bocca, con i denti, passando per l’esofago prosegue nello stomaco e finisce nell’intestino, che assorbe le sostanze nutrienti e espelle i residui come feci
L’APPARATO URINARIO
È formato dai reni, dalla vescica, dagli ureteri e dall’uretra. Ha il compito di filtrare il sangue depurandolo. Le sostanze di scarto sono eliminate come urina.
L’APPARATO RESPIRATORIO




Svolge la respirazione: preleva l’ossigeno dall’aria (inspirazione) e cede ad essa anidride carbonica (espirazione).
L’aria entra da naso e bocca, attraversa laringe, faringe e trachea e giunge nei bronchi e nei polmoni. Qui, negli alveoli, il sangue prende ossigeno e avviene lo scambio di gas.

Completa la mappa con l’aiuto delle parole chiave evidenziate nella pagina a fianco. Poi utilizzala per esporre a voce l’argomento.
È FORMATO DA
CHE COS’È?
FUNZIONE
È formato da miliardi di che formano i che costituiscono gli organi raggruppati in o apparati.
APPARATO LOCOMOTORE
Consente la eretta e il . DA COSA È COMPOSTO?
Sistema : composto dai muscoli.
Sistema �������������������������������������������������� : composto dalle ossa e dalle articolazioni.
APPARATO DIGERENTE
FUNZIONE
Svolge la cioè trasforma e le sostanze nutritive del cibo. Espelle residui con le DA COSA È COMPOSTO?
Denti, esofago, , , ano.
APPARATO URINARIO
FUNZIONE
Filtra il e lo DA COSA È COMPOSTO?
Reni, vescica, ,
APPARATO RESPIRATORIO
FUNZIONE
Preleva
dall’aria (INSPIRAZIONE) e cede l’ (ESPIRAZIONE).
DA COSA È COMPOSTO?
Naso, bocca, , , trachea, bronchi, , con gli alveoli.

Inquadra il QR code e ascolta il podcast di Pop. Nella sua trasmissione “Scienze in tasca” si parlerà oggi dell’importanza dello sport. Poi prova a rispondere alle seguenti domande. Se ne hai bisogno, ascolta il podcast più volte.
● Perché lo sport fa bene al corpo?
Perché fa diventare più alti all’istante
Perché aiuta cuore, polmoni e muscoli a lavorare meglio
Perché fa venire più fame
Perché fa perdere tempo
● Cosa aiuta a migliorare lo sport secondo Pop?
La magia
L’allenamento e l’impegno
Mangiare molti dolci
Arrabbiarsi quando si perde
● Quale emozione lo sport può aiutare a ridurre?
La gioia
La paura del buio
La rabbia o le preoccupazioni
La curiosità
● Che cosa insegna il lavoro di squadra?
Che è meglio fare tutto da soli
Che insieme si ottengono risultati migliori
Che le regole non servono
Che bisogna sempre vincere
● Secondo Pop, che cosa possono imparare i bambini dagli sport individuali?
A non ascoltare gli altri
Pazienza e autocontrollo
Solo come essere più veloci
Come barare meglio
● Cosa invita a fare Pop alla fine del podcast?
Restare sempre fermi per non sudare
Giocare solo ai videogiochi
Provare a muoversi di più durante la settimana
Non fare nessuna attività fisica
Indica se le seguenti affermazioni sono Vere (V) o False (F).
● Lo sport aiuta anche il cervello a funzionare meglio. V F
● Fare sport serve solo a vincere le gare. V F
● Anche gli sport individuali insegnano disciplina e autocontrollo. V F
● Muoversi aiuta a sentirsi più sereni e felici. V F
● Lo sport non ha nulla a che fare con le emozioni. V F
Organizza un piccolo diario del movimento per una settimana: ogni giorno annota per quanto tempo ti sei mosso e che attività hai fatto (corsa, gioco, sport, camminata). Alla fine descrivi in poche frasi se ti sei sentito più energico o più sereno.
Le ossa sono costituite da una sostanza organica, l’osseina, da sali minerali e da acqua. Ciascun componente conferisce particolari proprietà alle ossa, ad esempio l’osseina è responsabile della flessibilità ossea, mentre i sali minerali danno resistenza e rigidità. Scopriamo insieme cosa succede se immergiamo un osso di pollo nell’aceto, una sostanza capace di sciogliere i sali.
COSA FARE?
1 Riempi di aceto il barattolo.
2 Immergi completamente l’osso nel barattolo e chiudi con un coperchio, per evitare che l’odore dell’aceto ti infastidisca.
3 Lascia riposare per una settimana e osserva ogni giorno se noti cambiamenti.
4 Dopo una settimana, preleva l’osso e lavalo abbondantemente con acqua fresca.
5 Noterai che l’osso ha perso rigidità ed è diventato gommoso e flessibile.


COSA SERVE?
● un barattolo di vetro
● un osso di pollo
● aceto sufficiente a riempire il barattolo


IO SCIENZIATO
Scrivi le tue ipotesi e confronta le tue idee con quelle della classe.
● Perché l’osso prima era duro e rigido? Che cosa lo rende gommoso e flessibile? Quale sostanza è stata sciolta dall’aceto?
1 Completa le catene.
cellule formano formano formano formano organismo
2 Collega i tessuti alla loro funzione.
TESSUTO MUSCOLARE
TESSUTO CONNETTIVO
TESSUTO EPITELIALE
TESSUTO NERVOSO
3 Indica con una ✘ la risposta corretta.
● Qual è la funzione principale delle ossa nell’apparato locomotore?
Fornire struttura e supporto
Proteggere i polmoni
● Che cosa permette ai muscoli di farci muovere?
La loro capacità di espandersi
La loro capacità di contrarsi e rilassarsi
funzione di sostegno
funzione di risposta
funzione di movimento
funzione di protezione
● Qual è il compito delle articolazioni?
Collegare i muscoli
Collegare le ossa e facilitare il movimento
● Quale parte dell’apparato locomotore è rigida e solida?
Le articolazioni
Le ossa
4 Descrivi il percorso che l’aria compie nel sistema respiratorio quando inspiriamo, scrivendo i nomi degli organi coinvolti.
5 Metti in ordine le fasi della digestione, numerando da 1 a 4, poi completa con le seguenti parole:
stomaco · saliva · bocca · intestino · crasso · villi · esofago
Dopo la bocca, il cibo passa attraverso l’ , e arriva nello
Il processo di digestione inizia nella
, dove il cibo viene masticato dai denti e impastato con la
I residui del cibo passano attraverso l’intestino e vengono espulsi dall’ano.
Nell’ tenue il cibo è trasformato ormai in sostanze nutritive, che vengono assorbite dai ������������������������������������������������������ e passano al sangue.
6 Indica nell’immagine i nomi degli organi che compongono l’apparato urinario e scrivi quale compito svolge.

Il compito dell’apparato urinario è
• Ti è piaciuta questa unità?
• Quale argomento ti è piaciuto di più? Perché?
• Colora di il quadratino degli esercizi che hai trovato facili e di quello degli esercizi che hai trovato difficili.
L’apparato riproduttore ha il compito di garantire la riproduzione della specie umana, cioè la nascita di nuovi individui che ereditano le caratteristiche dai genitori. È diverso nell’uomo e nella donna.
L’apparato è in grado di svolgere il suo compito dopo la pubertà, periodo della vita in cui il corpo di un bambino cresce e cambia per diventare corpo da adulto. Tutto è controllato dagli ormoni, che sono come piccoli “messaggeri chimici” che dicono al corpo quando è il momento di cambiare.


L’apparato femminile
È formato, quasi per intero, da organi interni. I
più importanti sono:
● le ovaie, due ghiandole che producono le cellule uovo, gli ovuli;
● l’utero, una cavità con le pareti muscolari che accoglie e protegge il bambino prima della nascita e si contrae con forza per spingerlo fuori quando è pronto per nascere;
● la vagina, anch’essa di tessuto muscolare, collega l’utero con l’esterno.
L’apparato maschile
I principali organi dell’apparato maschile sono situati all’esterno del corpo.
Distinguiamo:
● i testicoli, due ghiandole che producono le cellule riproduttive maschili, gli spermatozoi;
● il pene, percorso da canali che convogliano all’esterno gli spermatozoi e l’urina.
STUDIO CON METODO
RICERCO INFORMAZIONI
Come cambia il corpo durante la pubertà? Quali sono le differenze in questa fase tra uomo e donna? Parlane con la tua famiglia o con l’insegnante, senza imbarazzo. Conoscere il nostro corpo ci aiuta a rispettarlo.
Dalla fecondazione alla nascita
Gli spermatozoi hanno una lunga coda che permette un movimento ondeggiante per raggiungere l’ovulo. Dall’incontro di uno spermatozoo e un ovulo nasce una nuova cellula, che darà origine a un nuovo essere umano: questo momento è chiamato fecondazione.
Il periodo dello sviluppo del nuovo organismo, nell’utero della donna, dura normalmente 40 settimane, circa nove mesi, ed è chiamato gestazione o gravidanza.
Dopo pochi giorni, la cellula fecondata è un embrione, cioè una minuscola creatura già capace di sviluppare tutti gli organi vitali, i sistemi e gli apparati. Contemporaneamente, intorno all’embrione si forma la placenta, una specie di sacca protettiva piena di un liquido detto amniotico. A partire dalla decima settimana, l’embrione prende il nome di feto e assomiglia ogni giorno di più a un essere umano: sono visibili braccia, gambe e piccoli movimenti.
Il feto si muove, “nuotando” nel liquido amniotico, è nutrito e ossigenato dal sangue della madre, che gli giunge tramite la placenta, a lui collegata mediante il cordone ombelicale.
Al termine della quarantesima settimana avviene il parto. Dopo la nascita, il cordone ombelicale viene tagliato e il neonato comincia a respirare da solo con i polmoni e a nutrirsi del latte materno con la bocca. fecondazione




si formano le ossa e i tratti del viso



si avvicina il momento del parto si sono formati tutti gli organi
STUDIO CON METODO
RICERCO INFORMAZIONI
Descrivi lo sviluppo di un nuovo essere umano, usando i seguenti termini:
● ovulo
● embrione
● placenta
● feto
● fecondazione
● utero
● cordone ombelicale
● spermatozoo

L’apparato circolatorio ha un compito molto importante: permette la circolazione del sangue che trasporta ossigeno e nutrienti a tutte le cellule e raccoglie anidride carbonica e le sostanze di rifiuto.
Sono i condotti all’interno dei quali avviene la circolazione del sangue, dal cuore a tutte le parti del corpo e viceversa. Questi condotti si distinguono in arterie, vene e capillari.
● Le arterie trasportano il sangue dal cuore a tutto il corpo. La più grande arteria del nostro corpo è l’aorta, che fuoriesce dalla parte sinistra del cuore.
● Le vene trasportano il sangue dalle diverse parti del corpo al cuore. Hanno pareti più sottili delle arterie e sono meno elastiche. Le vene di maggiori dimensioni sono la cava inferiore e la cava superiore, che finiscono nella parte destra del cuore.
● I capillari sono vasi sanguigni sottilissimi che si diramano sia dalle arterie sia dalle vene. Attraverso le loro pareti, l’ossigeno e le sostanze nutritive vengono ceduti alle cellule, da cui vengono prelevate le sostanze di rifiuto.
STUDIO CON METODO
SCHEMATIZZO E IMPARO
Inserisci nello schema le parole: arterie, vene. Poi esponi le caratteristiche dei vasi sanguigni.
Vasi sanguigni:
Cuore
Capillari e cellule di tutto il corpo
Vasi sanguigni:
Il sangue è un tessuto liquido. I suoi compiti principali sono:
● depositare l’ossigeno e le sostanze nutritive nei tessuti dell’organismo;
● rimuovere le sostanze di rifiuto prodotte dalle cellule.
Il sangue è composto da una parte liquida, di colore giallastro, il plasma, costituita principalmente da acqua. Nel plasma si trovano tre tipi di cellule:
● i globuli rossi trasportano l’ossigeno e rimuovono l’anidride carbonica; sono le cellule di gran lunga più numerose nel sangue. Hanno una forma tondeggiante, sono di colore rosso perché contengono ferro;
● i globuli bianchi sono più grandi e molto meno numerosi dei globuli rossi. Svolgono una preziosa azione di difesa dell’organismo dalle malattie. Ne esistono svariati tipi che si distinguono in base al loro specifico compito;
● le piastrine intervengono nel caso ci sia un danno a un vaso sanguigno, poiché permettono al sangue di coagularsi. Nel caso di piccole ferite, come i graffi, le piastrine si radunano intorno alla lesione e bloccano la fuoriuscita del sangue, formando la “crosticina”.
STUDIO CON METODO
OSSERVO E IMPARO
Osserva l’immagine e rispondi.
● Quale componente del sangue ne costituisce la parte maggiore?
● Quali cellule sono meno numerose?
● Quali più numerose?
Piastrine
Plasma
Globuli bianchi
Globuli rossi
Coagulazione: significa passare dallo stato liquido a uno stato semisolido.
COME NASCONO LE CELLULE DEL SANGUE
I globuli rossi, le piastrine e la maggior parte dei globuli bianchi si formano nel midollo osseo. Le cellule del sangue hanno vita breve, da poche ore a 120 giorni; per questo ogni minuto milioni di nuove cellule entrano nel flusso del sangue.
plasma
piastrine
globuli bianchi globuli rossi
altre cellule
La parte destra del cuore riceve dalle vene il sangue povero di ossigeno e lo spinge nei polmoni.
Il cuore è un muscolo involontario formato da tessuto muscolare. È un organo cavo, grande come una mano chiusa a pugno e si trova tra i polmoni, rivolto verso la parte sinistra del corpo. Ha il compito di pompare il sangue nei vasi sanguigni.
L a struttura
Una robusta parete divide il cuore in due parti separate fra loro: una destra e una sinistra. A sua volta ogni parte è divisa in due cavità: atrio e ventricolo. Ogni atrio è posto sopra al ventricolo e comunica con esso. Gli atri ricevono il sangue, i ventricoli lo spingono fuori dal cuore.
destro
Ventricolo destro

Atrio sinistro
Ventricolo sinistro
La parte sinistra riceve il sangue ossigenato dai polmoni e lo spinge nell’arteria aorta e da essa in tutti gli organi.
L a funzione
Il cuore batte senza sosta: si contrae e poi si dilata, funzionando come una pompa. Ogni minuto spinge 5 litri di sangue ai polmoni e poi in tutto l’organismo. Nella vita di un essere umano, il cuore batte circa tre miliardi di volte!
STUDIO CON METODO
SCHEMATIZZO E IMPARO
Nel disegno colora la parte sinistra del cuore di rosso e la parte destra di azzurro.
Scrivi al posto giusto nei cartellini:
● atrio destro
● ventricolo destro
● atrio sinistro
● ventricolo sinistro

Quando il sangue è nei polmoni, attraverso le sottili pareti degli alveoli avviene lo scambio gassoso: i globuli rossi raccolgono l’ossigeno e rilasciano l’anidride carbonica.
Il sangue, ossigenato nei polmoni, attraverso la vena polmonare si dirige verso la parte sinistra del cuore.
Da qui viene pompato nell’aorta e in tutto il corpo, viaggiando attraverso le arterie. Poi, in canali sempre più piccoli, i capillari, raggiunge le cellule di tutti i tessuti.
Entrato nelle cellule, il sangue rilascia ossigeno e nutrimento e riceve anidride carbonica e scorie. Il sangue, scorrendo nelle vene, ritorna alla parte destra del cuore.
Da qui, attraverso l’arteria polmonare, viene spinto nei polmoni, per eliminare l’anidride carbonica ed effettuare un nuovo rifornimento di ossigeno. Il ciclo si ripete.
La circolazione sanguigna dell’uomo è detta doppia perché il sangue passa due volte dal cuore eseguendo due percorsi:
• la grande circolazione; dal ventricolo sinistro raggiunge tutte le parti del corpo per poi tornare al cuore, nell’atrio destro;
• la piccola circolazione; dal ventricolo destro passa ai polmoni e torna ossigenato al cuore, entrando nell’atrio sinistro.
STUDIO CON METODO
SCHEMATIZZO E IMPARO
Riordina, numerandole, le fasi in cui si svolge la circolazione.

CIRCOLAZIONE
Attraversa i polmoni: le cellule presenti nel sangue raccolgono l’ossigeno e rilasciano l’anidride carbonica.
Dopo aver prelevato l’ossigeno dai polmoni, il sangue si dirige al cuore e da qui viene pompato in tutto il corpo.
A questo punto il sangue ritorna al cuore attraverso le vene e, da qui, passa nei polmoni per effettuare un nuovo rifornimento di ossigeno.
1 Il sangue entra nelle cellule dei tessuti, cede ossigeno e nutrimento e raccoglie anidride carbonica e scorie.
Le numerosissime cellule del corpo umano non potrebbero essere rifornite di ossigeno e liberate dal pericoloso accumulo di anidride carbonica senza la circolazione del sangue nei vasi sanguigni. Far fluire, senza interruzione, il sangue spingendolo continuamente nelle arterie, nei capillari e nelle vene è il compito svolto dal cuore che si espande e si contrae ritmicamente. Pur trattandosi di un’azione automatica, il battito cardiaco è regolato da impulsi inviati dal cervello.


Il sistema nervoso è costituito dal tessuto nervoso, a sua volta formato da miliardi di cellule nervose, i neuroni. I neuroni sono collegati tra loro in modo da formare una rete complessa. Ogni volta che leggiamo, pensiamo, camminiamo, gli impulsi nervosi passano da una cellula all’altra, a una velocità elevatissima.
I neuroni sono cellule formate da un corpo cellulare che contiene il nucleo e da svariati prolungamenti. Il più lungo di questi è detto assone e termina con sottili fibre ramificate. I prolungamenti più corti sono detti dendriti: un neurone può averne fino a 200. L’assone trasmette impulsi nervosi, i dendriti li ricevono.
I compiti di coordinamento e di controllo del corpo umano sono affidati al sistema nervoso. A esso fanno capo anche le cosiddette funzioni superiori dell’uomo, come il pensiero, l’apprendimento, la memoria e il linguaggio. Il sistema nervoso viene suddiviso in due parti: sistema nervoso centrale e sistema nervoso periferico.
Il sistema nervoso centrale è composto dall’encefalo e dal midollo spinale. I suoi compiti sono:
• regolare le attività corporee;
• elaborare e coordinare le informazioni che provengono dal sistema nervoso periferico.
Il sistema nervoso periferico è composto dai nervi, che collegano il sistema nervoso centrale con tutte le parti del corpo.


Le emozioni sono regolate dal cervello.
L’encefalo
L’encefalo è la parte del sistema nervoso centrale racchiusa nel cranio. In esso si distinguono: cervello, tronco encefalico e cervelletto.
● Il cervello costituisce la parte più ampia dell’encefalo. Presenta una superficie rugosa, ricca di piegature e scanalature ed è diviso in due emisferi. È il centro di controllo del sistema nervoso: coordina le informazioni provenienti da ogni parte del corpo e prepara risposte adeguate. Nel cervello viene elaborata la maggior parte delle nostre funzioni consapevoli. È anche la sede del pensiero, delle emozioni, dell’apprendimento e della memoria.
● Il tronco encefalico controlla i processi vitali, come il battito del cuore e la respirazione.
● Il cervelletto è responsabile della coordinazione dei muscoli.
Dalla base del cervello parte il midollo spinale, un cordone lungo circa 45 cm, dello spessore di un dito, che corre all’interno della colonna vertebrale. Dal midollo spinale si ramificano i nervi per raggiungere tutte le parti del corpo.





















STUDIO CON METODO
SCHEMATIZZO E IMPARO





















Nel cervello visto dall’alto sono ben distinguibili i due emisferi, divisi da un profondo solco centrale.
Ricerca le informazioni nel testo e completa lo schema, indicando i compiti svolti da ogni parte dell’encefalo.
ENCEFALO
Funzioni del cervello: Funzioni del tronco encefalico: Funzioni del cervelletto:
I nervi trasportano informazioni dal sistema nervoso centrale alle varie parti del corpo e viceversa. Sono costituiti da fasci di fibre nervose attraverso cui viaggiano gli impulsi nervosi. Possiamo distinguere nervi autonomi, sensitivi e motori.
AUTONOMI
Convogliano le loro istruzioni a organi che regolano le funzioni vitali del nostro organismo. Per esempio, fanno battere il cuore o stimolano la digestione.
Trasmettono informazioni che possono pervenire dall’interno o dall’esterno del corpo. Per esempio, inviano le informazioni sul gusto degli alimenti, raccolte dalla lingua.
Nervi sensitivi e organi di senso
Inviano segnali dal sistema nervoso centrale ai muscoli dello scheletro, consentendo i movimenti volontari. Per esempio, rendono possibile allacciare le scarpe.
I nervi sensitivi sono collegati in particolare agli organi di senso: occhi, orecchie, naso, bocca e pelle ci mettono in contatto con il mondo esterno. In ciascuno di questi organi sono presenti cellule specializzate, i recettori sensoriali, che raccolgono informazioni e, attraverso i nervi sensitivi, le inviano all’encefalo.
Nervi autonomi: simpatici e parasimpatici
I nervi autonomi possono essere di due tipi e danno luogo a risposte diverse, anzi opposte, nello stesso organo. Distinguiamo:
● i nervi simpatici che, per esempio, in momenti di stress, aumentano il battito cardiaco, dilatano i bronchi, oppure, quando c’è poca luce, dilatano le pupille;
● i nervi parasimpatici che producono effetti opposti: per esempio diminuiscono i battiti cardiaci, restringono i bronchi per contribuire a conservare energie o a recuperarle, restringono le pupille quando c’è molta luce.
STUDIO CON METODO
SCHEMATIZZO E IMPARO
Completa lo schema.
Sistema nervoso
centrale periferico
Elenca gli organi:
Elenca i tipi di nervi:

Il senso della vista ci permette di vedere il mondo che ci circonda, riconoscendo forme, colori e dimensioni.
L’occhio è l’organo della vista.
L’occhio esterno
Gli occhi sono organi estremamente delicati e vulnerabili. Sono protetti all’interno di una cavità ossea, l’orbita, sotto alle ossa della fronte.
Se ci guardiamo allo specchio distinguiamo:
● le sopracciglia, che trattengono il sudore, e le ciglia, che proteggono l’occhio dalla polvere;
● le palpebre, che si possono chiudere per impedire l’ingresso di corpi estranei;
● la congiuntiva, una membrana sottile e trasparente che riveste la parte anteriore dell’occhio e si ripiega a tappezzare la parete interna delle palpebre;
● la cornea, una membrana bianca sotto la congiuntiva;
● l’iride, che può avere colori diversi;
● la pupilla, al centro dell’iride, che può restringersi e dilatarsi per permettere il passaggio della luce all’interno dell’occhio.
Il meccanismo della visione non avviene nella parte visibile dell’occhio, ma in quella interna, che ha una forma a globo e viene chiamata bulbo oculare.
Al suo interno, una lente trasparente ed elastica, il cristallino, varia la sua curvatura per proiettare le immagini provenienti dall’esterno su una membrana particolarmente sensibile, la retina.
La retina contiene i recettori della vista e da essa partono impulsi che, attraverso il nervo ottico, arrivano al cervello.
L’orecchio è l’organo dell’udito. Attraverso esso i suoni pervengono al cervello. Nell’orecchio distinguiamo tre parti. Ciascuna di esse è percorsa dalle onde sonore, prodotte dalla vibrazione dei corpi.
L’orecchio esterno è formato dal padiglione, la parte visibile dell’orecchio, e dal condotto uditivo, un canale dalle pareti lisce, in cui penetrano le onde sonore.
L’orecchio medio contiene il timpano, una sottile membrana a forma di ventaglio che, al passaggio del suono, vibra e trasmette il movimento a tre minuscoli ossicini, i più piccoli del corpo umano: il martello, l’incudine e la staffa.
L’orecchio interno contiene la coclea, una struttura a forma di chiocciola.
In essa, all’interno di una sostanza liquida, vi sono i recettori uditivi, cellule che recepiscono lo stimolo sonoro e lo trasmettono al nervo acustico
Quest’ultimo lo invia al cervello che interpreta i suoni.
L’equilibrio
ORECCHIO ESTERNO ORECCHIO MEDIO ORECCHIO INTERNO
Attraverso l’orecchio vengono trasmesse al cervello anche informazioni sulla posizione che il nostro corpo occupa nello spazio, permettendoci di rimanere in equilibrio. L’organo dell’equilibrio è il labirinto, formato dai canali semicircolari dell’orecchio interno.
STUDIO CON METODO
SCHEMATIZZO E IMPARO
Osservando l’immagine che illustra le varie parti dell’orecchio, completa la tabella. Poi spiega oralmente come avviene la ricezione dei suoni.
● Orecchio esterno:
● Orecchio medio:
● Orecchio interno:
Bulbo olfattivo


Recettore

L’olfatto e il gusto sono sensi che “lavorano” insieme reagendo alle molecole degli odori e dei sapori. Anche i loro organi, il naso e la lingua, sono molto vicini tra loro. Se sorseggiamo una bevanda, ne avvertiamo sia il sapore sia l’odore, entrambi importanti per apprezzarne la qualità.
I recettori dell’olfatto
I recettori dell’olfatto, o cellule olfattive, si trovano nella parte superiore della cavità nasale. Ne esistono centinaia di tipi, ognuno dei quali è sensibile a una sostanza.
Ogni cellula olfattiva si suddivide verso il basso in tante ciglia immerse nel muco. Verso l’alto, invece, si collega al bulbo olfattivo che, attraverso il nervo olfattivo, comunica col cervello.
Quando le molecole di un determinato odore raggiungono le cellule olfattive, le loro ciglia reagiscono e provocano l’invio di segnali al cervello: così percepiamo l’odore.
I recettori del gusto
Gli organi del gusto sono le papille gustative. Sono localizzate principalmente sulla superficie della lingua, ma sono presenti anche sul palato e nella gola. Ogni papilla è formata da un grappolo di circa 50 recettori, situati all’interno di un poro.
Quando cibi e bevande entrano in bocca, vengono dissolti dalla saliva. Le sostanze chimiche penetrano nei pori e raggiungono i recettori. Essi rispondono ai diversi sapori, generando impulsi che inviano al cervello attraverso la fibra nervosa.
Le papille gustative specializzate nel riconoscimento dei diversi sapori sono raggruppate in alcune zone della lingua, come mostrato nell’immagine.
I sapori vengono riconosciuti in determinate zone della lingua
L’organo del tatto è la pelle, che riveste tutto il corpo e contiene milioni di cellule recettori.
Attraverso la pelle riceviamo sensazioni tattili, quali la consistenza e la temperatura di ciò con cui veniamo a contatto. Al tatto è associata anche la percezione del dolore. La pelle è formata da diversi strati. Epidermide
L’epidermide è lo strato esterno, quello che vediamo. Nell’epidermide viene prodotta la melanina, una sostanza bruna grazie alla quale la pelle reagisce alla luce solare, diventando gradatamente più scura.
Il derma si trova sotto l’epidermide. Contiene vasi sanguigni, bulbi piliferi, da cui nascono i peli, ghiandole come quelle che producono il sudore e recettori cutanei, cellule specializzate che inviano al cervello svariati messaggi appena veniamo in contatto con un oggetto.
L’ipoderma è lo strato più profondo, costituito da cellule ricche di sostanze grasse. Agisce come isolante, cioè ci protegge dagli sbalzi di temperatura, e permette alla cute di scivolare sui muscoli sottostanti. In questo strato scorrono i vasi capillari.
STUDIAMO INSIEME
Divisi in gruppi, realizzate una presentazione alla classe per spiegare che cos’è un riflesso automatico a uno stimolo percettivo.
Discutete insieme sul riflesso, inteso come risposta “automatica” del cervello: vi sarà capitato di toccare un oggetto appuntito e di ritrarre da esso la mano ancora prima di averlo pensato.
Il cervello, in questo caso, reagisce a un’informazione sensoriale, pervenuta attraverso i recettori della pelle e dà l’ordine ai muscoli della mano di allontanarsi velocemente dall’oggetto per evitare di pungersi, indipendentemente dalla nostra volontà.
In ogni gruppo confrontate le vostre esperienze: tu e qualcuno dei tuoi compagni avete sperimentato un riflesso automatico a uno stimolo percettivo? Illustrate i casi più significativi e spiegateli brevemente attraverso didascalie.


L’APPARATO RIPRODUTTORE
Permette la generazione di un nuovo essere umano.
È diverso nella donna e nell’uomo: quello maschile comprende il pene e i testicoli, che producono gli spermatozoi, quello femminile comprende utero, ovaie, che producono gli ovuli, e vagina. Quando si incontrano, attraverso la fecondazione, queste cellule danno origine a un nuovo essere che si sviluppa durante la gestazione nel corpo della madre e nasce con il parto.
L’APPARATO CIRCOLATORIO

Permette la circolazione del sangue attraverso i vasi sanguigni: arterie, vene e capillari. Il sangue viene spinto dal cuore e compie la grande circolazione (dal cuore a tutte le parti del corpo e ritorno) e la piccola circolazione (dal cuore ai polmoni e ritorno). Così porta a tutte le cellule ossigeno e sostanze nutritive e raccoglie le scorie.






Svolge molte funzioni: riceve sensazioni dall’esterno e stimoli dall’interno dell’organismo (stanchezza, fame...) ed elabora risposte adeguate, coordina il corpo, ci permette di pensare, ricordare... È formato da cellule chiamate neuroni e suddiviso in due parti: il sistema nervoso centrale che è composto dall’encefalo (cervello, cervelletto e tronco encefalico) e dal midollo spinale; il sistema nervoso periferico che è composto dai nervi.
GLI ORGANI DI SENSO
Gli organi di senso sono: occhi (vista), orecchie (udito), naso (olfatto), bocca (gusto) e pelle (tatto). Essi possiedono cellule specializzate, i recettori sensoriali, che raccolgono informazioni dall’ambiente esterno e le inviano al cervello attraverso i nervi sensitivi.




































Completa la mappa con l’aiuto delle parole chiave evidenziate nella pagina a fianco. Poi utilizzala per esporre a voce l’argomento.
COMPRENDE
APPARATO RIPRODUTTORE
FUNZIONE
DA COSA È COMPOSTO?
un nuovo essere umano.
• UOMO: pene, che producono
• DONNA: utero, vagina,
che producono
APPARATO CIRCOLATORIO
FUNZIONE
Permette la del sangue, che porta e alle cellule e raccoglie le
DA COSA È COMPOSTO?
Cuore che compie e piccola , vasi sanguigni (
vene e
IL SISTEMA NERVOSO
).
FUNZIONE
Riceve e stimoli. Elabora il corpo. Ci permette di pensare e DA COSA È COMPOSTO?
• Sistema nervoso CENTRALE: composto dall’ e dal
• Sistema nervoso PERIFERICO: composto dai
GLI ORGANI DI SENSO
FUNZIONI
informazioni e le inviano al QUALI SONO? Occhi,

Inquadra il QR code e ascolta il podcast di Pop. Nella sua trasmissione “Scienze in tasca” si parlerà oggi dell’importanza del cervello. Poi prova a rispondere alle seguenti domande. Se ne hai bisogno, ascolta il podcast più volte.
● A cosa servono i neuroni?
A far crescere i capelli
A comunicare tra loro con segnali
A farci prendere il raffreddore
A colorare i sogni
● Quale parte del cervello aiuta a mantenere l’equilibrio?
Corteccia cerebrale
Cervelletto
Tronco encefalico
Naso
● Quando il cervello crea nuove connessioni?
Solo quando dormiamo
Quando impariamo qualcosa di nuovo
Solo quando siamo nervosi
Quando guardiamo la TV
● Di cosa ha bisogno il cervello per funzionare bene?
Tanta confusione
Sonno, movimento e buona alimentazione
Zucchero e videogiochi
Silenzio assoluto tutto il giorno
● Dove si trova il cervello e cosa lo protegge?
Nel petto, protetto dalle costole
Nella testa, protetto dal cranio
Nella schiena, protetto dalla colonna
vertebrale
Nella pancia, protetto dai muscoli
● Quale funzione svolge il tronco encefalico?
Aiutare a risolvere problemi di matematica
Controllare respirazione e battito cardiaco
Memorizzare poesie
Decidere i movimenti volontari
● Perché il sonno è importante per il cervello?
Perché fa crescere i capelli più velocemente
Perché riordina le informazioni del giorno
Perché spegne completamente tutte le funzioni
Perché serve per sognare soltanto
● Che cosa fa accendere la curiosità nel cervello?
Guardare sempre la stessa cosa
Ripetere un gesto senza pensare
Farsi domande e voler capire come funziona il mondo
Addormentarsi durante le lezioni
Rispondi con parole tue utilizzando le informazioni del podcast.
● Perché il cervello viene paragonato a una centrale di controllo?
● Cosa succede nel cervello quando apprendiamo qualcosa di nuovo?
● Quali abitudini quotidiane possono aiutare il cervello a lavorare meglio?
Realizza un modellino del cervello usando plastilina o pasta modellabile, dividendo le principali parti (corteccia, cervelletto, tronco encefalico). Fotografa o disegna il modello e descrivi in poche frasi che cosa rappresentano le parti create.
Completa il cruciverba, trovando le definizioni corrette.

Orizzontali
1 Protegge il cuore e i polmoni.
3 Organo che pompa il sangue in tutto il corpo.
5 Liquido rosso che circola nelle vene e nelle arterie.
6 Organi che usiamo per respirare.
8 Cellula femminile prodotta dalle ovaie.
9 Insieme delle ossa che protegge il cervello.
10 Il senso che permette di sentire i suoni.
Verticali
2 Organo principale del sistema nervoso, che controlla il corpo.
4 Sostanza che rende elastiche le ossa.
7 Senso che ci permette di vedere.
Metti in ordine le lettere nelle caselle evidenziate e scopri la parola misteriosa.
● La parola misteriosa è:
1 Indica con una ✘ la risposta corretta.
● Che cos’è l’apparato riproduttore?
Un insieme di organi che aiutano nella riproduzione
Un gruppo di muscoli che ci permettono di muoverci
Un sistema che controlla la respirazione
● Quale di questi organi fa parte dell’apparato riproduttore maschile?
Utero
Ovaie
Testicoli
● Quale funzione svolge l’utero nel corpo umano?
Produce cellule del sangue
Porta il cibo nello stomaco
Ospita e nutre un embrione durante la gravidanza
● Quale di queste non è una funzione dell’apparato riproduttore?
Protezione dal sole
Produzione di cellule riproduttive
Nutrimento degli embrioni
2 Quali sono gli elementi che formano l’apparato circolatorio? Cerchia quelli esatti e scrivi il nome sui puntini.





3 Collega ogni elemento alla sua descrizione.
Cellule che bloccano l’uscita del sangue da una ferita
Cellule che producono anticorpi e proteggono dalle malattie
Il viaggio del sangue attraverso il corpo
Cellule che trasportano ossigeno e raccolgono anidride carbonica
4
Indica con una ✘ se ogni affermazione è vera (V) o falsa (F).
● Il cervello si trova nella scatola cranica.
F
● Il neurone è una cellula nervosa. V F
● Il sistema nervoso centrale è formato dai nervi.
● Il cervello si divide in due emisferi.
● L’encefalo comprende cervello, cervelletto e tronco encefalico.
● Il cervello è la sede della memoria.
5 Completa con le parole corrette.
Il sistema nervoso è l’insieme degli organi che permettono al nostro corpo di
con l’ambiente esterno e di controllare le funzioni
F
F
F
F
, come la respirazione e il battito cardiaco.
Il cervello è responsabile di controllare i movimenti, le emozioni e le funzioni del nostro corpo. Al suo interno ci sono miliardi di cellule nervose chiamate . Queste cellule inviano e ricevono messaggi sotto forma di elettrici. Il midollo spinale si trova all’interno della vertebrale e collega il con il resto del corpo. I nervi sono come “cavi” che trasmettono i segnali dal cervello ai muscoli e agli organi e portano le informazioni dall’esterno al .
6 Scrivi i nomi nei cartellini. Poi usa i disegni per spiegare a voce come avviene la percezione delle immagini e dei suoni.
• Ti è piaciuta questa unità?
• Quale argomento ti è piaciuto di più? Perché?
• Colora di il quadratino degli esercizi che hai trovato facili e di quello degli esercizi che hai trovato difficili.
Fai una valutazione del percorso che hai svolto durante l’anno. Quanto nei sai degli argomenti affrontati? Hai acquisito un buon metodo di studio? Quali competenze hai sviluppato?
88 Il sistema solare
89 I moti della Terra
90 I moti della Luna
91 Le fonti di energia primarie
92 Le fonti di energia secondarie
93 La luce
94 Il suono
95 Cellule, tessuti, sistemi e apparati
96 Il sistema scheletrico
97 Il sistema muscolare
98 L’apparato respiratorio
99 L’apparato digerente
100 La digestione
101 Le sostanze nutritive
102 L’apparato urinario
103 L’apparato riproduttore
104 La gravidanza e la nascita
105 L’apparato circolatorio
106 Il cuore
107 La circolazione del sangue
108 Il sistema nervoso centrale
109 La vista
110 L’udito e l’equilibrio
116 L a stazione spaziale internazionale
Tutti a bordo, ma come? • Italiani sulla ISS
117 L a tuta spaziale
Com’è fatta?
118 Il Saturn V: il razzo dei viaggi lunari
119 I satelliti artificiali
Com’è fatto un satellite artificiale?
120 I pozzi petroliferi
121 Le auto elettriche
122 Le leve Le leve nel corpo umano
123 Misurare l’intensità del suono
125 Il circuito elettrico
126 STEM Lab
Costruiamo un semplice circuito
127 Che cosa sono le biotecnologie?
128 Le biotecnologie e la medicina
129 L a robotica
Perché usiamo i robot?
130 Come funziona un robot?
131 Robotica e Internet
Dove vediamo robot collegati alla rete?
132 Programma il tuo robot!
Insieme giochiamo ai robot

1. Costruisci un modellino di Sistema Solare, seguendo le istruzioni.
COSA SERVE?
● 9 sfere di polistirolo di varie dimensioni
● Una base di cartone rigido o polistirolo
● Bastoncini di legno
● Pennelli di varie dimensioni
COSA FARE?
1 Distribuisci le sfere di polistirolo assegnando una sfera grande per il Sole e sfere di dimensioni più piccole per ciascun pianeta. Ogni pianeta dovrà avere una grandezza proporzionata.
2 Dipingi ogni sfera con i colori caratteristici dei pianeti, poi lasciali asciugare completamente prima di passare al passaggio successivo.
3 Fissa il Sole al centro della base utilizzando la colla a caldo, con l’aiuto di un adulto.
4 Inserisci i bastoncini di legno nella base attorno al Sole, calcolando diverse lunghezze per rappresentare la distanza relativa dei pianeti.
5 Attacca ciascun pianeta all’estremità del rispettivo bastoncino, poi aggiungi l’etichetta con il nome.
6 Aggiungi dettagli, come gli anelli a Saturno e Nettuno, disegnandoli su un piccolo anello di cartoncino fissato attorno al pianeta.
7 Discuti la disposizione dei pianeti e le distanze relative dal Sole. Puoi anche parlare delle caratteristiche principali di ciascun pianeta, come atmosfera, temperature e caratteristiche geologiche.
STUDIO CON METODO COSTRUISCO MODELLI
● Colori acrilici o tempere (colori base: giallo, rosso, blu, verde, marrone, nero, bianco)
● Colla a caldo (con l’aiuto di un adulto)
● Pennarelli e pezzetti di cartoncino

Una volta terminato, il modellino può essere esposto in classe come un diorama del Sistema Solare. In alternativa al modello proposto, puoi appendere le sfere di polistirolo alla base con fili di nylon, senza usare i bastoncini. Il modello potrà poi essere appeso in aula.
1. Fai gli esperimenti e sottolinea le conclusioni giuste.
1 In un ambiente buio poni su un piano la lampada accesa.
2 Posiziona un mappamondo in modo che sia direttamente illuminato dal fascio di luce della lampada.
SVILUPPO LE COMPETENZE FACCIO ESPERIMENTI
1 In un ambiente buio, accendi una torcia
2 Dirigi il fascio di luce perpendicolarmente a una superficie scura.
3 Inclina la torcia senza cambiare la sua distanza dalla superficie illuminata.

CHE COSA SUCCEDE?
● Il fascio di luce illumina solo una parte del mappamondo: essa rappresenta la parte della Terra illuminata dal Sole durante il dì/la notte
● La superficie del mappamondo non illuminata rappresenta la parte della Terra che si trova immersa nell’oscurità durante il dì/la notte
● Ruotando lentamente il mappamondo, puoi simulare il moto di rotazione della Terra. La superficie prima illuminata, entrerà poco alla volta nella zona d’ombra, per ritornare alla luce dopo un giro completo del mappamondo su se stesso.
CHE COSA SUCCEDE?
● Il fascio di luce perpendicolare illumina una parte della superficie in modo netto; se inclini la torcia, la superficie illuminata si accresce, diventa più grande, ma la luce è più debole.
● Così, nel moto di rivoluzione, i raggi solari arrivano sulla superficie terrestre con inclinazioni diverse, determinando l’alternarsi delle stagioni.
● Quando la luce è più intensa, si è in estate/ inverno; quando è più debole, si è in estate/ inverno
1. Fai gli esperimenti e sottolinea le conclusioni giuste.
1 In un ambiente buio, volgi le spalle a una lampada accesa (la luce non deve essere troppo intensa).
2 Sostieni con la mano sinistra aperta, una pallina da tennis e tieni ben teso il braccio destro davanti a te.
3 Compi lentamente un giro su te stesso ruotando verso sinistra e osserva la superficie della pallina.

2. Completa le frasi.
La Luna compie:
● il movimento di rotazione intorno
● il movimento di rivoluzione intorno
● il movimento di traslazione intorno
La pallina rappresenta la Luna/Terra, la lampada il Sole, la tua testa la Terra. Mentre ruoti su te stesso, puoi vedere illuminata in modo alterno:
● tutta la parte della pallina rivolta verso di te;
● solo la parte destra o solo la parte sinistra della pallina;
● nessuna parte.
La lampada illumina parti diverse della pallina che tieni in mano, proprio come accade con la luce del Sole/della Terra nelle diverse fasi lunari.
3. Cancella per ogni frase il termine errato.
● Quando la faccia della Luna rivolta verso di noi non è illuminata, quindi non è visibile, si ha la Luna nuova/piena
● Quando il Sole illumina completamente la faccia della Luna rivolta verso di noi, si ha la Luna nuova/piena
1. Completa le frasi introducendo le parole mancanti. Se hai dubbi consulta il tuo testo.
● Le fonti primarie sono quelle fornite all’uomo dalla
● Tra le fonti primarie distinguiamo quelle:
, cosiddette perché sono fonti inesauribili che si rigenerano continuamente.
●
, cosiddette perché una volta sfruttate sono da considerarsi in progressivo esaurimento.
2. Classifica le fonti primarie di energia. Scrivi sui puntini.
3. Associa ogni immagine alla didascalia corretta e completa.


L’energia idroelettrica sfrutta l’energia dell’
L’energia geotermica è prodotta sfruttando il

eolica sfrutta il L’energia fotovoltaica cattura l’energia del

1. Indica se le affermazioni sono Vere (V) o False (F).
Le fonti secondarie di energia:
STUDIO CON METODO LEGGO E COMPRENDO
● si chiamano così perché non sono molto importanti per l’uomo. V F
● sono quelle che derivano dalle fonti primarie. V F
● sono i prodotti derivati dal petrolio e l’energia elettrica. V F
● derivano dalle fonti primarie per opera dell’uomo. V F
2. Nelle raffinerie, il petrolio grezzo viene riscaldato a temperature diverse, molto elevate, per ricavarne i derivati. Osserva lo schema che mostra come si ottengono i vari prodotti, poi svolgi le attività proposte.
Petrolio grezzo Fornace gas benzina nafta paraffina diesel olio combustibile olio lubrificante bitume
3. Scrivi accanto a ogni prodotto l’impiego che ne viene fatto. Puoi ricercare le informazioni nel testo o nel web.
4. Cancella in ogni frase l’aggettivo sbagliato.
● La benzina viene prodotta riscaldando il petrolio grezzo a una temperatura più elevata/meno elevata.
STUDIO CON METODO COLLEGO IMMAGINI E INFORMAZIONI
STUDIO CON METODO RICERCO INFORMAZIONI
STUDIO CON METODO LEGGO E COMPRENDO
● L’olio combustibile viene prodotto riscaldando il petrolio grezzo a una temperatura più elevata/ meno elevata
● Il bitume viene prodotto a una temperatura più elevata/meno elevata rispetto alla nafta.
● Il diesel viene prodotto a una temperatura più elevata/meno elevata rispetto alla benzina.
1. Completa la tabella.
STUDIO CON METODO COMPLETO TABELLE
CORPI LUMINOSI CORPI ILLUMINATI
Spiega quale caratteristica hanno:
Nomina qualche corpo luminoso:
Spiega quale caratteristica hanno:
Nomina qualche corpo illuminato:
2. Fai l’esperimento e sottolinea le conclusioni giuste.

SVILUPPO LE COMPETENZE FACCIO ESPERIMENTI
1 Col fascio di luce di una torcia accesa colpisci la superficie di uno specchio.
2 Con lo stesso fascio di luce colpisci un foglio da disegno bianco e ruvido.
CHE COSA SUCCEDE?
● La luce che colpisce lo specchio/il foglio ruvido fa comparire un riflesso, poiché viene deviata in una sola direzione.
● La luce che colpisce lo specchio/il foglio ruvido viene diffusa, cioè si propaga in tante direzioni creando una debole luminosità intorno al corpo.
3. Collega ogni fenomeno alla sua spiegazione.
La luce incontra un corpo opaco con la superficie non levigata e viene respinta in tutte le direzioni.
La luce incontra un corpo opaco con la superficie lucida e levigata e rimbalza in un’unica direzione.
STUDIO CON METODO COLLEGO E IMPARO
La luce che passa attraverso due corpi trasparenti cambia direzione quando incontra la superficie di contatto dei due corpi.
1. Fai l’esperimento e sottolinea le conclusioni giuste.
1 Un compagno batte fra loro due sassi, tenendoli tra le mani sott’acqua in una bacinella.
2 Ripetete la fase precedente ma, a turno, avvicinatevi alla bacinella tenendo in mano un bastone di legno che appoggerete con un’estremità nell’acqua e l’altra vicino al vostro orecchio.
CHE COSA SUCCEDE?
● Nella fase 1/2 il rumore dei sassi giunge all’orecchio attutito.
● Nella fase 1/2 il suono si avverte molto più nitido e forte.
SVILUPPO LE COMPETENZE FACCIO ESPERIMENTI
1 2

2. Con i compagni verifica la spiegazione scelta. Ricercate notizie sulla velocità delle onde sonore in diversi materiali tra cui l’aria, l’acqua e il legno. Realizzate una tabella in cui riportare i dati ottenuti.
MATERIALE
VELOCITÀ DEL SUONO (METRI PERCORSI IN 1 SECONDO) aria acqua legno
3. Rispondi richiamando alla memoria ciò che hai studiato.
STUDIO CON METODO RIELABORO INFORMAZIONI
● Perché un suono si propaghi: è utile tenere l’orecchio vicino alla sorgente sonora occorre un mezzo che trasmetta le vibrazioni della sorgente sonora
● Le onde sonore viaggiano più velocemente: nell’aria nei liquidi e nei solidi
● Puoi dedurre che: l’aria trasmette il suono meglio del legno il legno trasmette il suono meglio dell’aria
STUDIO CON METODO RICERCO E ORGANIZZO INFORMAZIONI

1. Indica con una ✘ se ogni affermazione è vera (V) o falsa (F).
● La cellula è l’unità di base di tutti gli esseri viventi.
● Tutte le cellule umane sono uguali tra loro.
● Il nucleo della cellula contiene il DNA.
STUDIO CON METODO LEGGO E COMPRENDO
● Le cellule del corpo umano lavorano tutte insieme per far funzionare l’organismo.
● Le cellule di uno stesso tipo si uniscono e formano un tessuto.
● Tutte le cellule vivono quanto l’individuo di cui fanno parte.
V F
V F
● Quando si riproducono, le cellule si dividono in due, creando una copia di se stesse. V F
● Una cellula può essere osservata a occhio nudo.
2. Divisi in gruppo, svolgete una breve ricerca su un tipo specifico di cellula, provate a disegnarne la struttura e raccogliete tutto il materiale in una presentazione che mostrerete alla classe.
3. Per ogni tessuto traccia una freccia di colore per indicare le sue caratteristiche e una freccia di colore per indicare la funzione che svolge.
È capace di contrarsi
STUDIO CON METODO RICERCO E ORGANIZZO INFORMAZIONI
STUDIO CON METODO SCHEMATIZZO E IMPARO
È formato da cellule disposte a strati Reagisce agli stimoli, elabora risposte
Le sue cellule hanno forme molto diverse
Tessuto muscolare Tessuto connettivo Tessuto epiteliale Tessuto nervoso
È formato da neuroni Riveste e protegge il corpo
Può compiere movimenti volontari o involontari
4. Collega i termini alla definizione corrispondente.
apparato
sistema
Sostiene e protegge gli altri tipi di tessuti
STUDIO CON METODO COLLEGO E IMPARO
Insieme di organi costituiti dallo stesso tessuto.
Insieme di organi differenti, formati da più tipi di tessuto, che collaborano allo svolgimento di una stessa funzione.
1. Elenca i compiti svolti dal sistema scheletrico. Il sistema scheletrico serve a:
● 2. Collega ogni parte dello scheletro con le sue componenti. Poi trascrivi, per ciascuna, le informazioni apprese.
arti superiori: arti inferiori:
scatola cranica:
ossa della faccia:
colonna vertebrale:
gabbia toracica:
3. Rispondi alle seguenti domande, ricordando quanto hai appreso.
● Quali sono i tre tipi principali di articolazioni?
● Qual è la funzione principale delle articolazioni mobili?
● Sai fare almeno due esempi di articolazioni fisse nel corpo umano?
● A cosa serve il liquido sinoviale?
1. Elenca i compiti svolti dal sistema muscolare.
Il sistema muscolare serve a:
METTO ALLA PROVA LE MIE CONOSCENZE

2. Leggi il testo; osserva le immagini riferite al braccio e cancella in ogni frase i termini errati.
Molti muscoli del nostro corpo lavorano in coppia per permettere i nostri movimenti. È il caso dei muscoli della coscia e dell’avambraccio. Mentre uno si allunga, l’altro si accorcia. Per questo sono detti muscoli antagonisti.
Braccio flesso
● Il bicipite si contrae/rilassa e si accorcia/allunga
● Il tricipite si contrae/rilassa e si accorcia/allunga
Braccio steso
● Il bicipite si contrae/rilassa e si accorcia/allunga.
● Il tricipite si contrae/rilassa e si accorcia/allunga
3. Segna con una ✘ i completamenti corretti.
● I muscoli scheletrici sono uniti a un osso mediante: articolazioni tendini
● I muscoli scheletrici sono formati da fibre: in grado di contrarsi e distendersi collegate in modo da formare una rete
STUDIO CON METODO LEGGO
Braccio flesso
Bicipite contratto
Tricipite rilassato
Tricipite contratto Braccio steso
4. Stendi e fletti il tuo braccio sinistro. Appoggiando la tua mano destra sul bicipite sinistro, ti sarà semplice constatare che si contrae e si allunga secondo il movimento che compi. Ripeti l’esperienza appoggiando la mano sinistra sul tricipite destro.
Bicipite rilassato
1. Scrivi i nomi degli organi nei cartellini corrispondenti.
● bronchi
● bronchioli
● faringe
● laringe
● cavità nasali
● trachea
● cavità orale
● polmoni

2. Leggi il testo, poi osserva le immagini e completa le frasi.
Il diaframma è un muscolo situato sotto ai polmoni. Ha la capacità di contrarsi verso l’alto formando una specie di cupola, oppure di appiattirsi.
● Durante l’inspirazione il diaframma si per permettere all’aria di nei polmoni.
● Durante l’espirazione il diaframma si per permettere all’aria di dai polmoni.


3. Fai l’esperimento e sottolinea la conclusione giusta.
1 Appoggia una mano sul tuo petto e posiziona l’altra sotto il tuo naso.
2 Inspira ed espira e prova a percepire che cosa cambia nel tuo corpo in questi due momenti.
CHE COSA SUCCEDE?
● Il movimento dei muscoli e delle ossa del torace permette al diaframma/ai polmoni di espandersi e comprimersi nelle due fasi della respirazione.

1. Scrivi i nomi degli organi nei cartellini corrispondenti.
● stomaco
● bocca
● fegato
● intestino tenue
● esofago
● intestino crasso
2. Indica per ogni tipo di dente la funzione che svolge nella masticazione del cibo.



STUDIO CON METODO COLLEGO E IMPARO
SVILUPPO LE COMPETENZE LAVORO CON LE IMMAGINI
Incisivo Canino Premolare Molare


3. Descrivi brevemente ciascuna parte del dente.


STUDIO CON METODO DESCRIVO CON L’AIUTO DELLE IMMAGINI
Smalto:
Polpa:
1. Attribuisci il nome agli organi raffigurati. Numerali, poi, secondo l’ordine in cui vengono percorsi dal cibo nelle fasi della digestione.
SVILUPPO LE COMPETENZE LAVORO CON LE IMMAGINI
2. Inserisci i termini mancanti in ciascuna fase della digestione.
Fase 1
Fase 2
STUDIO CON METODO METTO ALLA PROVA LE MIE CONOSCENZE
I tagliano, lacerano, triturano il cibo che viene intriso di
Gli elementi chimici presenti nella saliva iniziano a trasformare il cibo che prende il nome di
Le contrazioni delle pareti dell’
spingono il nello dove rimane per alcune ore. Rimescolato dai movimenti delle pareti di questo organo e trasformato dai prende il nome di
Fase 3
Fase 4
Il viene inviato nell’ . Quasi tutti i componenti utili presenti nel cibo sono assorbiti nelle curve e nelle spire di questo organo. Altre sostanze prodotte dal e dal
completano il processo di scomposizione. Il cibo è completamente trasformato in un liquido lattiginoso che prende il nome di
Il arriva all’ che ha il ruolo di assorbire l’acqua. Le scorie rimanenti verranno espulse sotto forma di
I cibi non sono tutti uguali. In base alle sostanze nutritive che contengono, vengono classificati in tre gruppi principali.
• Alimenti ricchi di proteine, come la carne, il pesce, le uova, il latte, i formaggi e i legumi (fagioli, lenticchie, piselli…). Le proteine servono a rinnovare le cellule.
• Alimenti energetici, come il pane, la pasta, il riso, i dolci, i grassi animali (burro, strutto) e quelli vegetali (olio, margarina). Le sostanze ricche di zuccheri forniscono energia “pronta per l’uso”, quelle ricche di grassi costituiscono invece una “energia di riserva”.
• Alimenti ricchi di sali minerali e vitamine, come la frutta e la verdura, ma anche il latte. I sali minerali e le vitamine favoriscono la crescita, aiutano a mantenere sani i tessuti e a prevenire le malattie.

A latte, uova, carote, albicocche, radicchio, verdure arancioni
B1 cereali integrali, germe di grano, lievito di birra, semi, legumi
B2 yogurt, lievito di birra, mandorle, cereali integrali, legumi
B12 fegato, latte, formaggio, uova, carne, pesce
C agrumi, fragole, kiwi, patate
D pesce, latte, uova
E oli vegetali, semi, nocciole, pinoli, mandorle
K ortaggi a foglia verde
1. Completa il cruciverba sulle vitamine. Nella colonna colorata comparirà il nome di un alimento che contiene la vitamina B12!
1. Un frutto rosso che contiene vitamina C ma non è l’arancia.
2. Contiene vitamina B12 e… può essere di Colombo!
3. Quelli a foglia verde contengono vitamina K.
4. Contengono vitamina B1.
5. Contiene le vitamine A, B12 e D.
6. Ne ha chi è coraggioso… e contiene vitamina B12.
7. Contengono vitamina C.
8. Un frutto estivo che contiene vitamina A.
9. Quelli vegetali contengono vitamina E.
1. Completa le frasi con le parole date:
urina • reni • apparato urinario • apparato digerente.
● Gli organi che hanno il compito di ripulire il sangue dalle scorie sono i
● Le scorie solide prodotte dalla digestione vengono espulse dall’ , le scorie liquide vengono eliminate attraverso l’
● Il fluido costituito dalle sostanze indesiderate e dall’acqua in eccesso si chiama
2. Scrivi i nomi degli organi nei cartellini corrispondenti.
● Vescica
● Uretra
● Rene destro
● Rene sinistro
● Uretere destro
● Uretere sinistro

3. Collega ciascun organo alla sua funzione.
Espelle l’urina all’esterno
Immagazzina l’urina
Collegano i reni alla vescica
Filtrano il sangue
4. Leggi il testo, poi rispondi a voce alle domande. Le scorie prodotte dall’organismo sono raccolte nel sangue. Per permetterci di rimanere in salute, tali sostanze di scarto devono essere filtrate ed eliminate. Questo processo è affidato all’apparato urinario che filtra il sangue ed elimina le scorie e l’acqua in eccesso producendo l’urina. Il sangue depurato viene poi ridistribuito nel corpo.
● Dove sono raccolte le sostanze di scarto che vengono prodotte dall’organismo?
● Quale compito svolge l’apparato urinario? STUDIO CON METODO LEGGO E COMPRENDO
1. Cancella in ogni frase la parola sbagliata.
L’apparato riproduttivo:
● è l’unico che nella specie umana è diverso/uguale tra l’uomo e la donna;
● permette la riproduzione, cioè la morte/nascita di individui;
● nell’uomo presenta gli organi principali situati all’interno/all’esterno del corpo;
● nella donna presenta quasi tutti gli organi all’interno/all’esterno del corpo;
2. Scrivi i nomi degli organi nei cartellini corrispondenti.
ovaie • pene • testicoli • vagina • utero

STUDIO CON METODO METTO ALLA PROVA LE MIE CONOSCENZE
3. Completa ciascuna delle frasi.
● Le cellule riproduttive femminili si chiamano
● Le cellule riproduttive maschili si chiamano
● La fecondazione avviene quando

STUDIO CON METODO LEGGO E COMPRENDO
STUDIO CON METODO COLLEGO E IMPARO

STUDIO CON METODO LEGGO E COMPRENDO
4. Indica con una ✘ se le affermazioni sono vere (V) o false (F).
Gli spermatozoi sono:
● prodotti nei testicoli. V F
● molto più grandi degli ovuli. V F
● pochissimi. V F
Gli ovuli sono:
● prodotti nelle ovaie. V F
● molto più piccoli degli spermatozoi. V F
● fecondati dagli spermatozoi. V F
Dalla fusione di un ovulo e uno spermatozoo:
● non nasce nulla. V F
● nasce una nuova cellula. V F
● inizia la gravidanza o gestazione. V F
1. Completa il testo.
Lo stato della donna che porta nel proprio utero un ovulo fecondato si chiama o . Ha la durata di circa mesi, cioè settimane durante le quali si forma un nuovo essere umano.
La cellula uovo, fecondata, si suddivide prima in parti, poi in e così via. Dopo pochi giorni è un cioè una minuscola creatura che possiede la capacità di sviluppare tutti gli , i sistemi e gli apparati. A partire dalla decima settimana circa, l’embrione prende il nome di e assomiglia ogni giorno di più a un essere umano. Al termine della quarantesima settimana il bambino è pronto per lasciare il corpo della madre attraverso un processo che si chiama
2. Indica con una ✘ se le affermazioni sono vere (V) o false (F).
Il bambino appena nato:
● non è formato del tutto.
V F
● deve imparare molte cose. V F
● apre gli occhi.
● non è in grado di percepire suoni, odori e gusti.
● impara subito a respirare coi suoi polmoni.
● impara subito a succhiare il latte.
V F
V F
V F
V F
● non può riconoscere e memorizzare nulla per diverse settimane. V F
3. Leggi il testo, poi rispondi a voce alle domande.
STUDIO CON METODO LEGGO E COMPRENDO

STUDIO CON METODO LEGGO E COMPRENDO

STUDIO CON METODO LEGGO E COMPRENDO
Poco dopo il parto, le mammelle della mamma sono pronte a produrre il latte, l’alimento perfetto per un neonato. L’allattamento può essere svolto anche con latte in polvere che, sciolto in acqua, si mette nel biberon. Man mano che il bambino cresce, il solo latte non può più soddisfare tutti i bisogni energetici e, a sei mesi, la maggior parte dei bambini comincia a consumare altri cibi facilmente digeribili, come frutta o passati di verdura. Comincia così lo svezzamento. A tre anni i bambini, in genere, consumano gli stessi cibi consumati dai genitori.
● L’allattamento di un neonato può avvenire solo col latte materno?
● In che cosa consiste lo svezzamento?
● Quali sono i primi cibi che il neonato consuma dopo l’allattamento?
1. Collega ogni tipo di vaso sanguigno alle sue caratteristiche.
arterie
vene capillari
●
STUDIO CON METODO COLLEGO E IMPARO
Trasportano il sangue dalle diverse parti del corpo al cuore
Sono sottilissimi e si diramano sia dalle arterie che dalle vene
2. Completa il testo con le parole date.
Trasportano il sangue dal cuore a tutto il corpo
STUDIO CON METODO LEGGO E COMPRENDO
difesa • liquida • globuli bianchi • piastrine • plasma • coagularsi ossigeno • globuli rossi • anidride carbonica • crosticina
Il sangue è composto da una parte che si chiama In esso galleggiano tre tipi di cellule:
che trasportano
● i che intervengono nella dell’organismo dalle malattie;
● le
che intervengono nel caso ci sia un danno a un vaso sanguigno e permettono al sangue di formando la
3. Cerchia in ogni frase le parole corrette.
● Il plasma costituisce la componente maggiore/minore del sangue.
● Nel sangue i globuli rossi sono le cellule più/meno numerose.
● I globuli bianchi, rispetto ai globuli rossi, sono più piccoli/più grandi
● Nelle piccole ferite, le piastrine facilitano/bloccano la fuoriuscita del sangue.
STUDIO CON METODO LEGGO E COMPRENDO
● Il sangue coagula, cioè passa dallo stato solido a quello liquido/dallo stato liquido a quello solido
4. Leggi il testo, poi rispondi a voce alle domande.
STUDIO CON METODO LEGGO E COMPRENDO
Una goccia di sangue contiene circa 5 milioni di globuli rossi. Essi contengono emoglobina, una sostanza che conferisce loro il colore rosso. Ogni molecola di emoglobina trasporta atomi di ferro che attraggono e assorbono ossigeno nei polmoni. Durante il loro viaggio all’interno dell’organismo, i globuli rossi depositano ossigeno nei tessuti. Sono estremamente flessibili e possono introdursi anche nei vasi sanguigni più sottili.
● Che cos’è l’emoglobina?
● Che cosa trasporta?
● Come viene catturato l’ossigeno nei polmoni?
● Come sono i globuli rossi?
1. Osserva l’immagine e completa il testo.
Una robusta parete divide il cuore in due parti: una e una
A loro volta ciascuna delle due parti è divisa in cavità: e
Ogni è posto sopra a un e comunica con esso.
ricevono il sangue, i lo spingono fuori dal cuore.
Atrio destro

2. Completa la tabella.
RICEVE
cuore parte sinistra
cuore parte destra
3. Fai l’esperimento e completa le conclusioni.
CONTARE LE PULSAZIONI
1 Siediti e rilassati, poi appoggia indice e medio sull’arteria di uno dei tuoi polsi: sentirai il sangue pulsare. Per 1 minuto, conta le pulsazioni che avverti e registra il risultato nella prima riga della tabella.
2 Ripeti l’esperimento nelle condizioni indicate in tabella e registra i dati.
ATTIVITÀ
In stato di riposo
Dopo aver corso per 1 minuto
Dopo aver corso per 3 minuti
Dopo aver salito 3 piani di scale
NUMERO DI PULSAZIONI IN 1 MINUTO
SPINGE
SVILUPPO LE COMPETENZE FACCIO ESPERIMENTI

CHE COSA SUCCEDE?
● Le pulsazioni variano perché, sotto sforzo, il corpo richiede più ossigeno, così il cuore batte più velocemente per inviare più e soddisfare la richiesta.
1. Completa gli schemi inserendo sulle frecce: ossigeno • anidride carbonica
Cellule dei tessuti
sangue carico di
sangue carico di
sangue carico di
2. Nell’immagine indica nei cartellini: grande circolazione e piccola circolazione. Poi completa i testi che si riferiscono alle due fasi.
● Mentre il sangue attraversa i ������������������������������ , negli alveoli, ha luogo lo scambio gassoso: le cellule del sangue raccolgono l’ e rilasciano l’
● Il sangue ossigenato, dai si dirige al , e da qui viene pompato in tutto il corpo attraverso le ; poi in canali sempre più piccoli raggiunge tutti i tessuti.
● Una volta entrato nelle cellule dei tessuti il sangue rilascia
e riceve e
● Il sangue ritorna al cuore attraverso le
e, da qui, nei , per eliminare l’ ed effettuare un nuovo rifornimento di
sangue carico di
Cellule dei tessuti

1. Completa il testo con le parole date.
apprendimento • cervello • emozioni • funzioni • memoria pensiero • risposte • sistema nervoso
STUDIO CON METODO LEGGO E COMPRENDO
La parte più ampia dell’encefalo è costituita dal . È il centro di controllo del
. Elabora la maggior parte delle nostre consapevoli.
Coordina le informazioni provenienti da ogni parte del corpo e prepara le
adeguate.
È la sede del , delle , dell’ e della
2. Collega ciascuna parte del sistema nervoso centrale alla funzione che svolge, poi al disegno.
Cervello
Cervelletto
È un lungo cordone che parte dalla base del cervello e corre all’interno della colonna vertebrale.
È la parte più ampia dell’encefalo.
Controlla i processi vitali come la respirazione e il battito cardiaco.
È il responsabile della coordinazione dei muscoli.
3. Indica con una ✘ se ogni affermazione è vera (V) o falsa (F).
STUDIO CON METODO COLLEGO E IMPARO



































STUDIO CON METODO LEGGO E COMPRENDO
● Il sistema nervoso centrale è composto dal cervello e dal midollo spinale. V F
● Il cervello si trova nella colonna vertebrale. V F
● Il midollo spinale è una struttura che trasporta i messaggi tra il cervello e il resto del corpo. V F
● Il cervello è responsabile dei pensieri, dei movimenti e delle emozioni. V F
● Il sistema nervoso centrale è l'unica parte del sistema nervoso che controlla i riflessi. V F
● Il cervello è protetto dalla gabbia toracica. V F
● Dal midollo spinale si ramificano i vasi sanguigni. V F
1. Scrivi il numero che, nell’immagine, corrisponde alle diverse parti dell’occhio esterno e, per ognuna, esponi a voce il compito che svolge.
1 sopracciglia
2 cornea
3 iride
4 palpebra
5 pupilla
6 congiuntiva
7 ciglia
STUDIO CON METODO SCHEMATIZZO

2. Metti in corrispondenza le parti del bulbo oculare con le spiegazioni.
Nervo ottico
3. Fai l’esperimento e sottolinea la conclusione giusta.
COME VEDIAMO I CARTONI ANIMATI?
1 Disegna un pesciolino su un disco di cartoncino.
2 Disegna sull’altro disco una boccia di vetro.
3 Incolla i due dischi con i disegni all’esterno.
4 Lega un elastico a ciascun lato del disco di cartone.
5 Arrotola gli elastici, poi distendili: il disco ruoterà rapidamente su se stesso.
STUDIO CON METODO COLLEGO E IMPARO
Lente elastica e trasparente che può variare la sua curvatura.
Membrana particolarmente sensibile che contiene i recettori della vista.
Comunica al cervello gli impulsi dei recettori visivi.
CHE COSA SUCCEDE?
SVILUPPO LE COMPETENZE FACCIO ESPERIMENTI
● Vedrai il pesce all’interno del vaso di vetro! Questo avviene perché ogni immagine sulla retina rimane impressa per un secondo/un decimo di secondo
● Ciò consente al nostro cervello di “legare” varie immagini e percepirle come una sola.
● Questo fenomeno ci permette di vedere i disegni animati senza accorgerci che stiamo vedendo una serie di disegni in rapida successione.
1. Che cos’è? Rispondi agli “indovinelli”, poi riporta nel disegno il numero corrispondente a ogni parte dell’orecchio.
1 È una struttura a forma di chiocciola.
2 Trasmette i messaggi sonori al cervello.
3 È la parte visibile dell’orecchio.
4 Membrana che vibra al passaggio dei suoni.
5 Canale in cui penetrano le onde sonore.
6 Minuscoli ossicini che trasmettono le vibrazioni.
7 È l’organo dell’equilibrio.
2. Fai l’esperimento e completa le conclusioni con i termini assegnati.
cervello • equilibrio • canali semicircolari labirinto • recettori sensoriali
CAMBIAMENTI DI POSIZIONE
1 Prova a ruotare su te stesso, per qualche secondo, oppure fai una capriola.
2 Subito dopo prova a camminare dritto.
CHE COSA SUCCEDE?
STUDIO CON METODO RICAVO INFORMAZIONI DA IMMAGINI


SVILUPPO LE COMPETENZE FACCIO ESPERIMENTI
● Faticherai a mantenerti in perché, mentre giravi su te stesso, i che si trovano nei tre che costituiscono il dell’orecchio si sono adeguati alla condizione. Essi, per un po’ di tempo, continuano a trasmettere la sensazione di movimento al prima di registrare la tua mutata posizione.
● Ecco perché sembra che la testa... giri ancora!
1. Scrivi i nomi nei cartellini corrispondenti.

2. Completa il testo con le parole date.
STUDIO CON METODO RICAVO INFORMAZIONI DA IMMAGINI

STUDIO CON METODO LEGGO E COMPRENDO
ciglia • sostanza • nervo olfattivo • cellule olfattive • cervello bulbo olfattivo • muco • cavità nasale
I recettori dell’olfatto sono le . Si trovano nella parte superiore della Ne esistono centinaia di tipi, ognuno dei quali sensibile a una . Ognuna di esse si suddivide verso il basso in tante immerse nel . Verso l’alto, invece, si collega al che, attraverso il
comunica col
3. Indica con una ✘ se ogni affermazione è vera (V) o falsa (F).
STUDIO CON METODO LEGGO E COMPRENDO
● L’olfatto è il senso che ci permette di percepire gli odori. V F
● Le molecole degli odori arrivano al naso attraverso l’aria. V F
● Le cellule olfattive si trovano sulla lingua. V F
● Gli odori sono riconosciuti dal cervello, che riceve segnali dalle cellule olfattive. V F
● L'olfatto non è collegato al senso del gusto. V F
● Se sorseggiamo una bevanda, ne avvertiamo sia il sapore sia l’odore. V F
● Il senso dell’olfatto può avvertire i pericoli, come il fumo di un incendio. V F
1. Completa il testo con le parole date. recettori • gola • poro • cervello • palato • papille gustative • lingua • sapori
STUDIO CON METODO LEGGO E COMPRENDO
Gli organi del gusto sono le della bocca. Sono localizzate principalmente sulla superficie della , ma sono presenti anche sul e nella
Ognuna di esse è formata da un grappolo di circa 50 situati all’interno di un . Quando cibi e bevande entrano in bocca, essi rispondono ai diversi generando impulsi che inviano al
2. Leggi il testo, poi esegui quanto richiesto.
percezione di odori e sapori
Hai senz’altro sperimentato che, quando si ha il raffreddore, spesso si attenua la capacità di percepire odori e sapori. Quando assaporiamo un cibo, da esso si sprigionano sostanze odorose che normalmente raggiungono le cellule olfattive nella cavità nasale passando dall’interno della bocca. Il raffreddore blocca questo delicato passaggio poiché causa una maggiore produzione di muco nel naso. In questo modo le molecole portatrici di odori non possono raggiungere i recettori nasali che non percepiscono più il profumo o l’odore del cibo, o lo avvertono in modo più tenue.
Segna con una ✘ la frase errata.
Gusto e olfatto sono strettamente collegati.
Gusto e olfatto sono indipendenti.
Quando assaporiamo un cibo, utilizziamo sia il gusto sia l’olfatto.
3. Scrivi i sapori al posto giusto sulla lingua.
● amaro
● acido
● salato
● dolce
STUDIO CON METODO LEGGO E COMPRENDO


STUDIO CON METODO SCHEMATIZZO
1. Scrivi ogni termine nel cartellino opportuno:
● derma
● ipoderma
● epidermide

STUDIO CON METODO METTO ALLA PROVA LE MIE CONOSCENZE
2. Cancella in ogni frase la parola sbagliata.
La melanina:
● è una sostanza giallognola/bruna;
● è prodotta dalla pelle in presenza/in assenza di luce solare;
● rende la pelle gradatamente più chiara/scura
3. Per ogni affermazione, indica con una ✘ a quale strato della cute si riferisce.

CUTE
Epidermide Derma
STUDIO CON METODO LEGGO E COMPRENDO
STUDIO CON METODO LEGGO, COMPRENDO E SCHEMATIZZO
Tessuto sottocutaneo
È lo strato più profondo.
È lo strato superiore.
Contiene i recettori cutanei collegati al cervello.
Contiene vasi sanguigni e ghiandole, per esempio quelle che producono sudore.
Permette alla cute di scivolare sui muscoli sottostanti.
Produce melanina.
Agisce come isolante proteggendoci dagli sbalzi di temperatura.

Siete pronti a diventare dei veri scienziati e raccontare una scoperta della medicina che ha salvato tante vite? Create insieme il vostro podcast, lavorando in piccoli gruppi.
Ecco le 4 fasi del nostro lavoro:
1 FASE
Da svolgere collettivamente
In questa prima fase, il vostro gruppo dovrà scegliere la scoperta scientifica che pensate abbia salvato la vita di tante persone. Pensate a grandi malattie del passato che oggi curiamo con dei banali farmaci da banco. Cosa fare?
● Brainstorming di gruppo: discutete tra voi quali scoperte della medicina vi vengono in mente. Potrebbe essere un vaccino, la penicillina, i raggi X o magari qualcosa di lontano nel tempo! Votate o decidete insieme quale scoperta volete raccontare.
● Ricerca semplice: una volta scelta la scoperta, cercate informazioni su di essa: chi l’ha fatta? Quando è stata fatta? Come è stata fatta? Perché è importante? Come ha cambiato la vita delle persone? C’è qualcosa di strano o particolare legato a questa scoperta? È avvenuta per caso?
● Scelta degli strumenti utili: libri di scienza per bambini, siti web sicuri (con l’aiuto di un adulto), disegni e appunti (usate fogli e matite per prendere appunti e fare piccoli disegni che vi aiutino a ricordare le informazioni).
FASE
SCRITTURA DEL TESTO 2
Da svolgere collettivamente
Ora che avete tutte le informazioni, è il momento di trasformarle in un testo che potrete leggere nel vostro podcast. Immaginate di parlare ai vostri amici! Cosa fare?
● Suddivisione dei compiti: decidete chi racconterà cosa. Magari uno racconta la scoperta, un altro lo/la scienziato/a, e un altro ancora perché è importante.
● Scrittura delle frasi: scrivete frasi brevi e chiare. Usate parole che conoscete bene.
● Ripetizioni e prove: leggete il testo ad alta voce più volte per vedere se suona bene e se è facile da capire. Chiedete l’aiuto dell’insegnante per correggere eventuali errori.
● Strumenti utili: quaderno e penna/matita, per scrivere la bozza del testo. Se preferite utilizzate tablet o computer, usando un programma di scrittura semplice (come Blocco Note o Google Documenti)
È il momento di registrare le vostre voci! Non preoccupatevi se non siete perfetti, l’importante è divertirsi e far sentire la vostra passione per la scienza. Cosa fare?
● Trovare un posto tranquillo: cercate un angolo della classe o della scuola dove non ci sia troppo rumore.
● Parlare chiaro: parlate a voce alta e chiara, come se steste raccontando una storia a qualcuno.
● Alternarsi: ricordatevi di alternarvi nel parlare, come avevate deciso nella Fase 2.
● Registrazione: registrate il vostro podcast. Potete fare più tentativi e scegliere quello che vi piace di più.
● Strumenti utili: smartphone o tablet (la maggior parte dei telefoni e tablet ha un’app per registrare la voce, spesso si chiama “Registratore Vocale” o “Memo Vocali”), microfono esterno (è facoltativo, ma se avete anche un piccolo microfono per computer, la qualità dell’audio sarà migliore).
Finalmente, il vostro podcast è pronto! Ora potete ascoltarlo e condividerlo con gli altri. Cosa fare?
● Ascoltare insieme: ascoltate il vostro podcast di gruppo. Cosa vi piace di più? C’è qualcosa che avreste potuto fare diversamente?
● Condivisione: presentate il vostro podcast agli altri gruppi. Saranno curiosi di conoscere la vostra scoperta scientifica!
● Feedback: ascoltate i commenti dei vostri compagni e dell’insegnante. Ogni consiglio è utile per migliorare la prossima volta.
● Strumenti utili: dispositivo di riproduzione (lo stesso smartphone o tablet che avete usato per registrare, un computer con delle casse, una LIM).
5 FASE Da svolgere individualmente
AUTOVALUTAZIONE
Ho lavorato con i compagni bene e volentieri bene solo in alcune occasioni con difficoltà
Ho rispettato le regole (tempi, attenzione, impegni) sempre qualche volta mai
Ho ascoltato le opinioni dei compagni sempre con attenzione quasi sempre con attenzione con scarsa attenzione
Leggere e comprendere i testi è stato facile a volte faticoso difficile
Ho partecipato al lavoro cercando di svolgere i miei compiti da solo/a chiedendo aiuto solo se in difficoltà con l’assistenza continua dell’insegnante
Sono soddisfatto/a del lavoro molto abbastanza poco


Samantha Cristoforetti a bordo della ISS.
La Stazione Spaziale Internazionale (International Space Station, o ISS) è una speciale base orbitante che opera a circa 400 km di altezza, grande più o meno quanto un campo di calcio. Possiamo considerarla la casa dell’umanità nello Spazio, ma anche un laboratorio scientifico dove è possibile effettuare esperimenti in assenza di peso, per capire come gli esseri umani possano vivere nello spazio per lunghi periodi.
A bordo di essa vivono astronauti di varie nazionalità, in gruppi di sei alla volta, che vi abitano e lavorano per periodi di circa sei mesi.
Tutti a bordo, ma come?
I Porti di Attracco (Docking Ports) sono delle porte speciali che permettono alle navicelle che trasportano gli astronauti di attraccare alla ISS e consentono di arrivare e ripartire dalla Stazione. Ci sono poi gli Airlocks, le porte usate dagli astronauti per uscire all’esterno della stazione e fare le Passeggiate Spaziali, le Extra Vehicular Activities (EVA), rimanendo agganciati, con cavi, al corpo della Stazione.
Italiani sulla ISS
Diversi astronauti italiani hanno partecipato a missioni sulla Stazione Spaziale Internazionale (ISS). Ricordiamo Umberto Guidoni, Roberto Vittori, Paolo Nespoli, Luca Parmitano, Walter Villadei. Samantha Cristoforetti, detta Astrosamantha, è stata la prima donna astronauta italiana a volare nello spazio ed è stata, nel 2022, per la missione Minerva, la prima donna europea a ricoprire l’incarico di comandante dell’ISS.
1. Cerca la Stazione Spaziale Internazionale in cielo. É possibile vederla ad occhio nudo. Apparirà come una stella che si muove nel cielo.
● Collegati al sito della NASA oppure scansiona il QR-code per scaricare l’app che ti permetterà di sapere in che giorno e a che ora la Stazione Spaziale Internazionale passerà sopra la tua città.
La tuta spaziale è un prodotto tecnologico altamente avanzato che, anche in un ambiente avverso come lo spazio vuoto, permette agli astronauti non solo di sopravvivere, ma anche di lavorare in condizioni di massima sicurezza. Potremmo definirla come un’ astronave a forma di uomo. È molto più di un semplice vestito: è un sistema di supporto vitale completo. Il suo scopo principale è mantenere l'astronauta in vita e al sicuro durante le passeggiate spaziali (le EVA). Una tuta spaziale può pesare fino a 130 kg sulla Terra, ma nello spazio sembra molto più leggera.
Com'è fatta?
Una tuta spaziale è composta da diverse parti con varie funzioni. Il casco contiene microfoni per comunicare, protegge la testa, dà ossigeno e ha una visiera protettiva. Lo zaino (PLSS) contiene tutto l'occorrente per sopravvivere all’esterno dell’astronave: il rifornimento di ossigeno, sistemi di depurazione dell'aria dall’anidride carbonica, un serbatoio per l’acqua potabile, una radio per le comunicazioni, un sistema di raffreddamento, un secondo serbatoio di ossigeno per le emergenze e batterie. È il vero cuore della tuta. Il busto rigido superiore è la parte principale, come la corazza di un'armatura, dove si collegano braccia e zaino. Nella parte frontale si trova il modulo di visione e controllo, dal quale l’astronauta può controllare i dispositivi contenuti nello zaino, manovrando alcune valvole. I guanti sono riscaldati, proteggono le mani e permettono di muoverle anche nello spazio. Il vestito di raffreddamento è uno strato interno, come una maglietta intima, pieno di tubicini in cui scorre acqua per mantenere al giusto livello la temperatura corporea dell'astronauta.
STUDIO CON METODO
SCHEMATIZZO E IMPARO
Scrivi nei cartellini vuoti i nomi delle parti della tuta.
COLLEGO E IMPARO
Collega il problema all’elemento della tuta che lo risolve.
Mancanza di aria
Pericolo di abbagliamento
Temperature estreme
La visiera del casco
Zaino (PLSS)
Vestito di raffreddamento


STUDIO CON METODO
GUARDO VIDEO E COMPRENDO
il Saturn V è stato un razzo spaziale molto potente, utilizzato dalla NASA durante le missioni Apollo negli anni '60 e '70. Con un'altezza di circa 110 metri, era il razzo più alto mai costruito e poteva trasportare fino a 140 tonnellate di carico utile nello spazio. Questo razzo ha giocato un ruolo fondamentale nel portare gli astronauti sulla Luna, compresa la famosa missione Apollo 11 nel 1969, quando un astronauta per la prima volta camminò sulla superficie lunare. Il Saturn V è stato progettato per essere altamente efficiente e sicuro, con tre parti che si separavano in sequenza durante il volo. Grazie al suo straordinario potere e alla sua tecnologia avanzata, il Saturn V ha aperto la strada a molte scoperte spaziali e rimane un simbolo dell'ingegneria e dell'innovazione umana.
Guarda il video dello sbarco sulla Luna, poi rispondi alle domande.
● Qual è il nome scelto per il Lem dagli astronauti?
Eagle Diamond Moonwalk Star
● Qual è stata la probabilità iniziale di successo secondo Collins?
● Quale problema hanno affrontato gli astronauti durante la discesa?
Problemi di comunicazione
Carenza di carburante
Malfunzionamento del computer
Nessuna delle precedenti
● Come ha reagito Armstrong quando si è accorto che qualcosa non andava durante la discesa?
È andato nel panico
È rimasto calmo
Ha urlato Ha pregato
I satelliti artificiali sono oggetti che gli esseri umani hanno lanciato nello spazio per svolgere molte funzioni utili. Inizialmente il loro scopo era quello di studiare il nostro pianeta, altri corpi celesti o in generale lo spazio. Successivamente sono stati introdotti i satelliti per la comunicazione che aiutano a trasmettere segnali telefonici e televisivi in tutto il mondo e i satelliti meteorologici che monitorano le condizioni atmosferiche per prevedere il tempo. Grazie a questi dispositivi, possiamo ricevere informazioni importanti, come gli avvisi di maltempo, e rimanere connessi con le persone lontane.
Com’è fatto un satellite artificiale?
I satelliti dispongono di numerosi strumenti, come telecamere e sensori, con cui osservano lo spazio esterno. Le antenne permettono le comunicazioni con la Terra ma ancora più importante è la memoria del computer di bordo, dove vengono conservate tutte le informazioni necessarie per le loro operazioni e i dati raccolti.
Un satellite ha anche bisogno di alimentazione per rimanere in orbita. Esistono due principali sistemi: uno è composto dalle batterie già presenti a bordo, l’altro è costituito dai pannelli solari, in grado di catturare la luce del Sole e trasformarla in energia elettrica. Per questo motivo i pannelli solari di un satellite vengono sempre orientati verso il Sole, e ruotano proprio come farebbe un girasole sulla Terra.

SVILUPPO LE COMPETENZE
RIPRODUCO MODELLI
Dopo aver osservato attentamente l’immagine, usando materiali facilmente reperibili a casa e a scuola, costruite un modellino di satellite artificiale.
Antenne

Alimentazione a pannelli solari
LEGGO E COMPRENDO
Dopo aver letto il testo, indica con una ✘ la risposta corretta.
● Come viene descritto un pozzo di petrolio?
Come una piccola cava
Come un lungo foro nel sottosuolo
Come una torre di legno
● A cosa serve la sostanza fangosa nel pozzo?
A colorare il petrolio
A rendere il pozzo più profondo
A raffreddare lo scalpello e rimuovere i detriti
● Dove è montato l’impianto di perforazione?
Su un albero
In un lago
Su una piattaforma o direttamente sul suolo
● Qual è la parte più evidente di un pozzo di petrolio?
Una torre metallica
Una piscina di acqua
Una pozza scura
● Cosa si deve fare al petrolio grezzo per utilizzarlo?
Congelarlo
Lavorarlo e distillarlo
Venderlo subito
SVILUPPO LE COMPETENZE
RIFLETTO E MI CONFRONTO
Rifletti e rispondi alle seguenti domande, poi confrontati con i compagni e le compagne.
● Perché è importante lavorare e distillare il petrolio grezzo? Quali sono le differenze tra perforazione a mare e perforazione a terra?
Un pozzo di petrolio può essere descritto come un lungo foro, praticato nel sottosuolo fino a una profondità variabile da poche centinaia di metri fino a 6-8 km. Serve a mettere in diretta comunicazione gli strati in cui è accumulato il petrolio con la superficie. Per la sua realizzazione, a seconda che si tratti di perforazione a mare (offshore) o perforazione a terra (on-shore), si usa un apposito impianto di perforazione, montato su una piattaforma o direttamente sul suolo.
La parte più evidente di un pozzo è una specie di torre metallica. Per perforare il terreno oggi si usa un grosso motore (top drive), sostenuto da un robusto gancio posto all’interno della torre. La velocità di perforazione dipende dalla tipologia di rocce e dalla profondità del giacimento di petrolio. Nel pozzo viene fatta circolare una sostanza fangosa, che serve a raffreddare lo scalpello e a rimuovere i detriti di roccia prodotti (cutting). Il fango ha anche lo scopo di prevenire crolli delle pareti del pozzo.
Al momento dell’estrazione il petrolio è detto petrolio grezzo. Per essere utilizzato per fini energetici, deve essere accuratamente lavorato e distillato, in specifici stabilimenti industriali, le raffinerie.

Le auto elettriche per funzionare, usano solo elettricità, quindi non producono fumo, non inquinano l’aria come fanno quelle a benzina; è un’energia più pulita che non inquina il pianeta.
Vediamo come funziona:
• L’auto elettrica ha una batteria gigante, simile a quella di un telefono cellulare, che si carica collegandola a una presa di corrente. Questa batteria immagazzina l’energia elettrica, proprio come una pila fa con i giocattoli.
• Quando si accende l’auto, la batteria invia energia al motore elettrico. Questo motore è diverso da quello di un’auto a benzina perché non ha bisogno di bruciare carburante.
• Il motore elettrico fa girare le ruote dell’auto che, grazie a questa energia, si muove in avanti, indietro e in tutte le direzioni proprio come un’automobile normale.
Quando la batteria si scarica, l’auto va collegata a una “stazione di ricarica”, simile a una grande presa di corrente, per “fare il pieno” di elettricità. Le stazioni di ricarica di solito sono situate in luoghi pubblici o nei parcheggi aziendali, ma le batterie possono anche essere ricaricate nei wallbox del garage o collegandole alla presa di corrente 220 Volts di casa tramite un kit di ricarica domestica. Così, l’auto è pronta per fare altri viaggi!

controller elettronico
spina
SVILUPPO LE COMPETENZE
LAVORO IN GRUPPO
batterie ricaricabili
motore elettrico
Divisi in gruppi, ricercate informazioni sulle auto elettriche più diffuse, sulla durata della batteria, sulla velocità media e su altre curiosità che le riguardano. Create poi una presentazione da condividere con la classe, evidenziando i vantaggi e gli svantaggi di questa tipologia di auto.
Le leve sono strumenti che ci aiutano a sollevare oggetti pesanti e a muoverli più facilmente. Cos’è una leva? È un’asta rigida che ruota attorno a un punto fisso, chiamato fulcro. Ci sono tre tipi di leve, a seconda della posizione del fulcro, della forza applicata e della resistenza:
Il fulcro si trova tra la forza applicata e il carico. Un esempio è la pinza. Quando esercitiamo pressione su un’estremità della pinza, l’altra estremità si chiude, permettendoci di afferrare o trattenere oggetti.
Il carico è posizionato tra il fulcro e la forza applicata.
Un esempio comune è la carriola. Quando spingiamo il manico, il carico si solleva più facilmente.
fulcro forza
resistenza
La forza applicata si trova tra il fulcro e il carico. Un esempio è la pinza per prendere il ghiaccio. Quando afferriamo il cubetto, il fulcro è il perno della pinza, la resistenza è rappresentata dal cubetto posto all’estremità.

Le leve nel corpo umano
Il corpo umano è pieno di leve che facilitano i movimenti. Le ossa funzionano come aste, mentre le articolazioni servono da fulcri e i muscoli lavorano per creare la forza necessaria per muovere le leve. Ad esempio, quando solleviamo un libro, il nostro braccio si muove come una leva di terzo genere. Il gomito è il fulcro, il bicipite applica la forza, e il libro è il carico. Più forte è il muscolo, maggiore sarà la forza che possiamo applicare alla leva.
SVILUPPO LE COMPETENZE
RACCOLGO INFORMAZIONI
Cerca un esempio di leva per ogni genere e spiega quali sono il fulcro, l’asta e la forza che le muove.
L’unità di misura dell ’intensità del suono è il decibel ( dB ).
L’intensità di un suono può essere misurata attraverso uno strumento chiamato fonometro. Questo dispositivo elettronico è progettato per rilevare e quantificare le intensità sonore in diversi ambienti chiusi, come uffici, fabbriche, scuole o all'aperto. Il fonometro converte le onde sonore in segnali elettrici che possono essere misurati e visualizzati su un display.
I fonometri sono utili per monitorare e controllare l'esposizione al rumore, che può avere effetti negativi sulla salute e sul benessere delle persone. Più aumentano i decibel, infatti, maggiore sarà il rischio di danni all’udito, perché maggiore sarà la pressione esercitata sull’orecchio.
Grazie a questo strumento, gli esperti possono dunque valutare se i livelli di rumore rientrano nei limiti di sicurezza stabiliti dalle normative sulla salute e prendere le appropriate misure di riduzione del rumore, come l'utilizzo di materiali fonoassorbenti, la limitazione del traffico in alcune aree e il rispetto delle normative in materia di emissioni sonore.
SVILUPPO LE COMPETENZE
LAVORO IN GRUPPO
Divisi in piccoli gruppi, provate a individuare le principali fonti di inquinamento acustico presenti dentro e fuori la vostra scuola (voci, campanella, clacson delle auto, ecc.) e, insieme, discutete sugli effetti che hanno sulla qualità della vostra vita.
● Sviluppate poi almeno due o tre proposte concrete, realistiche e realizzabili per ridurre l’inquinamento acustico nella vostra scuola.
● Infine, preparate un cartellone o una breve presentazione multimediale con cui condividere le vostre proposte alla classe e all’insegnante.
Fonometro digitale.


Studio di registrazione con pannelli fonoassorbenti.
L’INQUINAMENTO ACUSTICO
L’inquinamento acustico è un problema ambientale che riguarda l’eccessiva presenza di rumori fastidiosi o dannosi per la salute umana. Questo tipo di inquinamento può provenire da diverse fonti, come il traffico stradale, ferroviario e aereo, le attività industriali, i cantieri edili e persino i vicini di casa. L’inquinamento acustico può causare disturbi del sonno, stress, irritabilità e anche problemi di udito se esposti a livelli di rumore troppo elevati per un periodo prolungato.

Luxmetro.

Che cos'è l'energia luminosa?
L'energia luminosa è l'energia trasportata dalla luce. Possiamo vederla ogni giorno: quando il Sole illumina la Terra, quando accendiamo una lampadina o quando una torcia rischiara una stanza buia. La luce porta con sé energia e noi possiamo misurarla. Quando misuriamo la luce, di solito misuriamo due cose fondamentali: l'intensità luminosa, cioè la quantità di luce che una sorgente come una lampadina emette in una certa direzione. L'unità di misura dell’intensità è la candela (cd). Poi misuriamo l’illuminamento, cioè la quantità di luce che arriva su una superficie, come la pagina di un libro o la nostra scrivania. Misurare la luce ci aiuta a capire se un ambiente è abbastanza illuminato per leggere, lavorare o muoversi in sicurezza. Ci permette anche di risparmiare energia scegliendo le luci più adatte e ci aiuta a proteggere gli occhi da luci troppo forti.
Lo strumento per misurare
Lo strumento principale si chiama luxmetro. È piccolo e comodo da usare: basta puntarlo verso la fonte luminosa e sul display comparirà un numero in lux (lx), l’unità di misura della luce. È formato da due parti principali:
• il sensore è una piastrina che capta la luce. Quando la luce colpisce il sensore, genera un piccolo segnale elettrico.
• il display legge il segnale elettrico e lo trasforma in un numero che ci dice quanti lux ci sono.
SVILUPPO LE COMPETENZE
RIFLETTO E MI CONFRONTO
Perché è utile sapere quanta luce c’è in un ambiente? Pensaci e confronta la tua risposta con quella della tua classe.
L’INQUINAMENTO LUMINOSO
Misurare l’energia luminosa non serve solo a lavorare meglio: è anche un modo per prendersi cura dell’ambiente. Usare lampadine efficienti, spegnere le luci quando non servono e controllare che gli ambienti siano illuminati nel modo giusto aiuta a ridurre gli sprechi di energia. Un altro aspetto importante è l’inquinamento luminoso: quando le luci artificiali sono troppo forti o mal direzionate, illuminano il cielo e disturbano gli animali notturni, le piante e persino il nostro sonno. Ridurre l’inquinamento luminoso aiuta a rispettare la natura, risparmiare energia e permettere a tutti di vedere meglio le stelle.
Un circuito elettrico è un percorso chiuso attraverso cui può passare la corrente elettrica. A muoversi sono delle piccolissime particelle che non si vedono, chiamate elettroni. Il circuito, per funzionare, deve sempre essere completo: se anche un solo collegamento manca, il flusso di elettroni non può circolare. Gli elementi principali di un circuito:
IL GENERATORE DI ENERGIA
È ciò che fornisce l’elettricità, ad esempio una batteria.
I CONDUTTORI

Sono i fili che collegano i vari componenti. Devono essere fatti di materiali che lasciano passare la corrente, come il rame.

L’UTILIZZATORE
È ciò che utilizza l’energia elettrica: una lampadina, un LED, un motorino, un cicalino…
L’INTERRUTTORE

Serve per aprire e chiudere il circuito, cioè per accendere e spegnere.



Proviamo a costruire un semplicissimo circuito che accende una lampadina. Chiedi sempre aiuto a un adulto.
COSA FARE?
1 Collega un filo al polo positivo (+) della batteria.
2 Collega l’altra estremità del filo a un contatto della lampadina.
3 Collega un secondo filo dall’altro contatto della lampadina al polo negativo (-) della batteria.
4 Se vuoi usare un interruttore, inseriscilo in uno dei due fili.
5 Ora il circuito è completo: la lampadina dovrebbe accendersi!

SVILUPPO LE COMPETENZE
FACCIO ESPERIMENTI
Cambia l’utilizzatore.
Sostituisci la lampadina con:
● un motorino
● un cicalino
● un LED colorato
COSA SERVE?
● 1 batteria da 1,5 V o 4,5 V
● 2 fili elettrici con le estremità spellate
● 1 lampadina piccola o un LED
● 1 portalampada (facoltativo ma utile)

PROGETTO CIRCUITI
Disegna il tuo circuito.
Usa i simboli elettrici di base:
● Batteria:
● Lampadina:
● Interruttore:
Osserva le differenze: consumano la stessa energia? Funzionano tutti allo stesso modo? Confrontati con la classe.
Chiedi ai tuoi compagni di indovinare come funziona il tuo circuito.
La parola biotecnologia indica qualsiasi applicazione tecnologica che utilizza sistemi biologici, organismi viventi o loro derivati, per creare prodotti utili o risolvere problemi. Le biotecnologie esistono da molto tempo: quando impastiamo il pane o facciamo lo yogurt stiamo già usando dei microrganismi, come i lieviti e i fermenti lattici. Oggi, però, grazie alla tecnologia moderna, possiamo fare cose ancora più precise e utili.
Le biotecnologie ci aiutano a produrre sostanze molto importanti, come l’insulina per le persone diabetiche, che non possono produrla da sole. Anche i vaccini a volte sono prodotti con la biotecnologia.

PER L’AMBIENTE
Aiutano a depurare l’acqua di fiumi e terreni inquinati grazie a batteri che mangiano le sostanze nocive. Sono state anche prodotte bioplastiche che si degradano più facilmente.

Contribuiscono a coltivare piante più resistenti alla siccità o ai parassiti. Questo aiuta a produrre più cibo e a usare meno prodotti chimici come i pesticidi.

CURIOSITÀ POP
Un gruppo di scienziati ha creato la prima pianta che si illumina al buio producendo luce da sé, senza l’aggiunta di sostanze chimiche o la necessità di assorbire raggi UV. Il risultato è stato ottenuto grazie alla bioingegneria, con una modificazione genetica della pianta, utilizzando il corredo genetico di alcuni batteri luminescenti. Questo fa immaginare un futuro con molte piante auto luminescenti che potrebbero dare luce alle nostre strade e allo stesso tempo rendere l’aria più pulita.

Come abbiamo visto, le biotecnologie sono l’uso intelligente di esseri viventi (come piccolissimi funghi, batteri o cellule) per creare prodotti utili o risolvere problemi. Nel campo della salute, sono le nostre alleate più preziose. Spesso gli scienziati lavorano sul DNA, il “manuale d’istruzioni” che si trova nelle cellule di tutti gli esseri viventi e che ci rende unici, per capire come siamo fatti e come prevenire o curare tante malattie.
Gli scienziati possono identificare parti del DNA che non funzionano bene e capire perché una persona può ammalarsi. In alcuni casi, le biotecnologie permettono di correggere o sostituire parti del DNA, proprio come si restaura un’opera d’arte.
Conoscendo il DNA dei microrganismi è possibile insegnare loro a produrre sostanze utili. Grazie a questo, oggi molti farmaci sono più efficaci e hanno meno effetti collaterali.
Studiando il DNA è possibile capire se una persona rischia di sviluppare certe malattie. Questo permette ai medici di dare consigli personalizzati, controllare la salute con test mirati, intervenire prima che la malattia compaia.

SVILUPPO LE COMPETENZE
RIPRODUCO MODELLI
Costruisci il DNA.
Forma una piccola scala usando cannucce e pasta colorata, dove ogni colore rappresenta una parte diversa del DNA. Alla fine unisci tutti i pezzi e attorciglia la scala per farla diventare una doppia elica, proprio come quella del DNA.
La robotica è la scienza che studia e costruisce i robot: macchine che possono muoversi, capire l’ambiente e svolgere compiti al posto dell’uomo. I robot non sono solo personaggi da film. Oggi puoi vederli spesso in casa, in fabbrica, negli ospedali, negli aeroporti e persino nello spazio.
• Struttura: il corpo del robot (bracci, ruote, sensori…).
• Elettronica: la parte che fa funzionare i componenti.
• Programmazione: le istruzioni che dicono al robot cosa deve fare.
Perché usiamo i robot?
I robot vengono utilizzati perché possono aiutarci in molte attività che per gli esseri umani sarebbero faticose, rischiose o molto difficili. Per esempio, possono svolgere lavori pericolosi: alcuni robot entrano in luoghi dove c’è troppo calore, sostanze tossiche o pericoli che una persona non potrebbe affrontare in sicurezza, come una centrale danneggiata o un edificio crollato.
In altri casi i robot sono utili perché sanno fare operazioni molto precise. Certi bracci robotici usati negli ospedali riescono a muoversi con una delicatezza incredibile, più precisa persino della mano di un chirurgo.
Anche nelle fabbriche, dove bisogna montare piccoli pezzi sempre nello stesso modo, i robot lavorano con grande accuratezza senza stancarsi.
Infine, i robot possono aiutare le persone con difficoltà. In questo modo la tecnologia diventa un supporto gentile e utile per migliorare la vita di tutti.

LO SAPEVI?
Robot: viene dal ceco robota, che significa lavoro.

POP
Il robot più famoso nella storia del cinema è R2-D2 di Star Wars. Non solo è un eroe, ma è un perfetto esempio di robot: ha sensori per percepire, un cervello per elaborare e attuatori per muoversi e proiettare messaggi.
SVILUPPO LE COMPETENZE
PROGETTO MODELLI
Disegna il tuo robot.
Progetta un robot che risolve un problema reale (per esempio: un robot che ricicla, un robot pompiere…).
Scrivi cosa sa fare e che sensori usa.

Ogni robot, grande o piccolissimo che sia, ha una struttura molto simile, composta dai seguenti elementi:
Sono gli “organi” di senso del robot. Possono rilevare luce, distanza, suoni, temperatura e perfino colori.
UNITÀ DI CONTROLLO
È il “cervello” del robot. Riceve informazioni dai sensori e decide cosa fare. Di solito è un piccolo computer.
Sono le parti che si muovono: ruote, pinze, bracci, motori.
PROGRAMMAZIONE
Ogni robot funziona solo se qualcuno gli ha scritto un programma: una serie di comandi in ordine, proprio come una ricetta.




EDUCAZIONE CIVICA
ROBOT E LAVORO UMANO
La robotica toglie il lavoro agli uomini? La verità è che i robot svolgono i lavori pericolosi o ripetitivi. Questo permette agli esseri umani di dedicarsi a lavori più creativi, specializzati e, soprattutto, più sicuri. La tecnologia deve sempre migliorare la nostra qualità della vita e la nostra sicurezza, ma i robot non devono sostituire il valore delle persone È importante che la tecnologia sia usata in modo responsabile, garantendo sicurezza e collaborazione tra uomini e macchine.
Molti robot moderni sono collegati a Internet e possono comunicare tra loro o ricevere aggiornamenti. Questo permette loro di imparare nuovi compiti, migliorare le prestazioni e controllare informazioni in tempo reale. Un robot esploratore su Marte non potrebbe parlarci senza Internet. Invia le sue scoperte e le sue foto al centro di controllo sulla Terra usando potenti sistemi di comunicazione in rete.
Dove vediamo robot collegati
• Nei magazzini automatici che organizzano gli ordini online.
• Nei robot aspirapolvere, che mappano la casa tramite app.
• Nei droni che inviano immagini e dati.
• Nelle auto autonome, che leggono la strada e condividono dati di sicurezza.
Grazie a Internet, i robot diventano più intelligenti e utili, ma è importante proteggere le informazioni che scambiano.
EDUCAZIONE CIVICA
SICUREZZA ONLINE DEI ROBOT

Quando i robot sono connessi a Internet, è fondamentale proteggere i loro dati e le loro istruzioni da persone malintenzionate (hacker). Nella robotica, come in rete, dobbiamo sempre rispettare le regole di sicurezza e usare la tecnologia in modo responsabile, senza danneggiare noi stessi e gli altri. Per questo è importante usare password sicure, aggiornare i dispositivi e non condividere dati sensibili.
Molti robot non si limitano a seguire istruzioni fisse; imparano e prendono decisioni grazie all'Intelligenza Artificiale (IA). L'IA è come un cervello digitale che permette al robot di riconoscere oggetti, capire le voci o adattarsi a situazioni nuove. Quando parlate con un assistente vocale, state usando una forma di robotica software che si collega a Internet per cercare la risposta giusta.
CURIOSITÀ POP
LO SAPEVI?
Esistono i Nano-Robot, macchine piccolissime, più piccole di un capello, che gli scienziati sperano di usare in futuro per viaggiare all’interno del corpo umano e curare malattie dall’interno del nostro corpo.

CURIOSITÀ POP
ROBOTICA DIGITALE
Molti programmi online, come Scratch o Code.org, usano blocchi colorati invece di codici complessi. Questi blocchi sono come i mattoncini LEGO della programmazione. Prova a usarli per dare istruzioni a personaggi virtuali (i tuoi primi robot digitali).
La robotica non è solo da scienziati adulti. Anche tu puoi iniziare a programmare.
Programmare significa dare una sequenza precisa di istruzioni al robot (o al computer) in una lingua che lui capisce. Le istruzioni devono essere chiare, precise e nell’ordine giusto.
Esempio di Istruzione (Programma):
Leggi il sensore di distanza.
SE la distanza è minore di 10 cm, ALLORA gira a destra.
ALTRIMENTI continua dritto.
Insieme giochiamo ai robot
Fai un gioco per capire l’importanza delle istruzioni chiare.
Sarai un programmatore di robot.
• Scegli il tuo Robot: chiedi a un tuo amico di fare il Robot, cioè di eseguire le istruzioni.
• Scrivi il Programma: scrivi un programma con sole 3 istruzioni (ad esempio: Fai tre passi avanti, Alza il braccio destro, Gira su te stesso).
• Esecuzione: dai le istruzioni al robot. Il robot deve eseguirle esattamente come sono state scritte, senza interpretarle.
• Impara dall’Errore: se il robot fa qualcosa di sbagliato, di chi è la colpa? Sempre del programmatore. Devi imparare a dare istruzioni più precise.
SVILUPPO LE COMPETENZE
RIFLETTO E MI CONFRONTO
“I robot possono migliorare il mondo?”
Dividete la classe in due gruppi. Un gruppo dovrà sostenere che i robot possono migliorare il mondo, mentre l’altro dovrà spiegare perché i robot potrebbero creare dei problemi. Ogni gruppo ha qualche minuto per confrontarsi e scegliere almeno tre argomenti da presentare a favore della propria tesi. Alla fine, tutta la classe discute insieme su cosa ha imparato e quali soluzioni possono rendere l’uso dei robot più equilibrato e positivo per tutti.